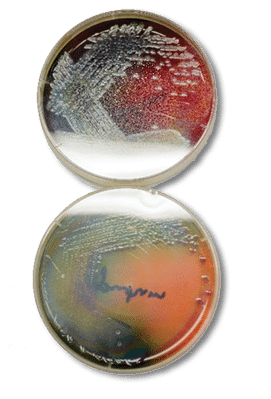
Petri dishes

Food Ventures in Wyoming:
A Resource and Regulatory Guide
B-1324
August 2018

Food Ventures in Wyoming:
A Resource and Regulatory Guide
Acknowledgment
The portions of this publication related to specialty crops were supported by the U.S. Department of Agriculture (USDA) Specialty Crop Grant Program, through a sub-grant from the Wyoming Department of Agriculture. Its aim is to enhance the competitiveness of specialty crops in Wyoming by increasing the production and consumption of fruits, vegetables, tree nuts, horticulture, and floriculture. wyagric.state.wy.us.
Disclaimer
This guide is intended for educational and informational purposes only and is not intended to be a legal opinion or legal advice.
The Food Ventures in Wyoming Project
In 2017, Lovell Inc. and University of Wyoming (UW) Extension partnered to help specialty crop producers improve their awareness about new regulations governing food production and sales.
Lovell Inc. is a nonprofit economic development organization located in Lovell, Wyoming. Among its goals are to retain and strengthen existing local businesses as well as recruit new businesses to the area. Their vision is to create a growing, healthy, and more diversified economy, now and for future generations. One of Lovell Inc.’s projects is to develop a local food hub and network existing Wyoming food hubs to enrich food producers, create a network of buyers and sellers, and to connect those buyers and sellers to new markets. Lovell Inc., working in collaboration with others, plans to build a greenhouse to increase regional food security and provide fresh produce year-round to markets throughout the state.
University of Wyoming Extension is a partnership of national, state, and county governments in which our state’s land-grant university offers resources to address public needs. Its aim is to strengthen the social, economic, and environmental well-being of families, communities, and agricultural enterprises. UW Extension educators and specialists work on, among other subjects, food safety and quality, the development of young children, sustainable agriculture, leadership development, personal resource management, governance skills, and economic development www.uwyo.edu/uwe.
Editor
This guide was assembled by Cole Ehmke, UW Extension specialist in rural entrepreneurship. Ehmke is based in the Department of Agricultural and Applied Economics within the UW College of Agriculture and Natural Resources.
Technical Reviewer
Linda Stratton, manager of the Wyoming Department of Agriculture’s Consumer Health Services, reviewed the document related to her office’s work and responsibilities.
Copy Editor and Photographer
Robert Waggener provided copy editing services and photographs. He is a Laramie, Wyoming-based freelance editor, writer, and photographer covering agriculture and natural resources in Wyoming and the West.
Layout and Design
Tana Stith provided document layout and graphic design for this publication. Stith is in UW Extension’s Office of Communications and Technology.
Suggested Reference
Ehmke, C. ed. (2018). Food Ventures in Wyoming: A Resource and Regulatory Guide, University of Wyoming Extension. B-1324.
Acronyms Used
CFRU.S. Code of Federal Regulations
CSACommunity Supported Agriculture
EINEmployer Identification Number
FDAU.S. Food and Drug Administration
FSMAFood Safety Modernization Act
GAPGood Agricultural Practices
HACCPHazard Analysis and Critical Control Points
IRSInternal Revenue Service
SARESustainable Agriculture Research and Education
SBDCSmall Business Development Center
SBIRSmall Business Innovation Research
USDAU.S. Department of Agriculture
WWOOFWorld Wide Opportunities on Organic Farms
Food Ventures in Wyoming:
A Resource and Regulatory Guide
Introduction1
The Laws That Govern2
Federal Agency Authority2
U.S. Department of Agriculture2
U.S. Food and Drug Administration2
National Organic Program4
Wyoming Food Laws4
Business Considerations7
Forms of Business Organization7
Business Licensing8
Taxes9
Zoning11
General Requirements13
Inspection13
High-Risk and Low-Risk Foods13
Good Manufacturing Practices16
Production In Home Kitchens16
Mobile Kitchens17
Labeling and Packaging17
Wyoming Labeling Requirements18
Sampling18
Meat and Poultry Products21
Federal Requirements21
Organic Labeling22
Nutritional Labeling22
Wyoming Rules22
Grade A Dairy25
Federal Requirements25
Wyoming Rules26
Poultry29
Federal Poultry Laws29
Wyoming Rules29
Nutritional Labelings30
Eggs31
Federal Egg Products Inspection Act31
Wyoming Rules32
U.S. Standards for Quality In Shell Eggs32
Wyoming Weight Classes for Consumer Grades for Shell Eggs33
Raw Fruits, Vegetables, and Nuts35
Federal Requirements35
Wyoming Rules36
Bees and Honey37
Federal Requirements37
Wyoming Apiaries37
Honey Processing38
Wildcrafting39
Federal Requirements39
Wyoming Rules40
Agritourism41
Farm Stores and Roadside Markets41
Alcohol42
Federal Requirements42
Wyoming Rules43
Resources45
Wyoming Agencies and Groups45
University of Wyoming College of Agriculture and Natural Resources46
Wyoming Small Business Development Center Network48
Grants and Loans49
Crop Insurance58
Volunteer Labor58
Agricultural Production59
Further Reading59
Appendix60
Introduction
Passage of the Wyoming Food Freedom Act by the Wyoming State Legislature in 2015 created the opportunity to develop value-added specialty crop businesses that had previously been prohibited. The act has essentially created two tracks for food processors to choose from: (1) ‘inspected’ processors, who can sell to consumers as well as restaurants, wholesalers, and retailers and also ship products across state lines; and (2) ‘food freedom’ processors, who are not required to process in inspected facilities and are limited to sales directly to an informed end consumer, a person who is the last to purchase any product, who does not resell the product, and who has been informed that the product was not produced in a licensed, regulated, or inspected facility.
This bulletin is intended to help Wyoming’s agricultural producers, small-acreage and small-scale farmers, home-based producers, and small-scale food processors understand the regulatory requirements for their industry. For those who sell under the Wyoming Food Freedom Act umbrella, it will define what is allowed and what is not. For those who want to take a value-added specialty crop business to the next level, this publication will give a sense of what must be addressed since the producers will become subject to numerous rules, including adherence to U.S. Food and Drug Administration (FDA) food safety regulations. Of course, the ultimate authority on any particular point for any food venture will be the relevant regulatory agency, so consider this guide as a complement to your interactions with those agency officials. In the end, we hope that this publication will help clarify how to legally sell the many food products our state produces.
We recommend reading through the relevant regulations to be aware of your responsibilities.

Introduction | 4
The Laws that Govern
Food products are regulated both by federal and local laws. Since all states must, at minimum, abide by federal statutes, there is a common basis for state regulations throughout the country. Some states, however, have instituted regulations in addition to the federal minimum, including Wyoming.
Many laws and regulations govern the production, processing, preparation, and sale of food. The type of food (e.g., produce or dairy), how it is prepared, processed, or packaged, and the quantity of production determines which agency has regulatory jurisdiction. Each agency has a different set of specific rules, and the various regulatory authority of each agency sometimes overlaps. The situation is further complicated by a set of interconnected state laws that enable Wyoming to implement some federal programs, and county or city requirements imposed by health departments and zoning authorities. Federal jurisdiction exists where a product is sold across state boundaries, which called ‘interstate commerce’. State jurisdiction exists where products are sold within a state’s boundaries, called ‘intrastate commerce’.
FEDERAL AGENCY AUTHORITY
The U.S. Department of Agriculture (USDA) and the U.S. Food and Drug Administration (FDA) share primary responsibility for regulating the nation’s food supply. Additional details about the USDA’s and FDA’s regulation of particular products are provided in the relevant sections throughout this guide.
U.S. Department of Agriculture
The USDA has regulatory authority over meat, poultry, and eggs. The most notable laws that give USDA this authority are the: (1) Federal Meat Inspection Act of 1906; (2) Poultry Products Inspection Act of 1957; (3) Humane Methods of Slaughter Act of 1958; and (4) Egg Products Inspection Act of 1970.
The USDA, or a USDA-equivalent program delegated to the state, inspects meat, poultry, and eggs/egg products to ensure safety standards are met.
U.S. Food and Drug Administration
The U.S. Food and Drug Administration (FDA) regulates all foods that are not covered by USDA regulations, and is authorized by the: (1) Federal Food, Drug, and Cosmetic Act of 1938; and the (2) Fair Packaging and Labeling Act of 1967. These laws allow the FDA to (1) set safe tolerances for unavoidable poisonous substances that may be found in or added to foods; (2) set forth standards for identification, quality, and fill-of-container; (3) authorize factory inspections and enforcement actions such as injunctions, seizures, and prosecution; and (4) regulate the labeling of food products.
Food Safety Modernization Act
The Food Safety Modernization Act (FSMA) of 2011 authorizes the FDA to take a preventive approach to food safety issues in the U.S. food supply. This is a shift in approach where previously the focus had been on detection of foodborne illness. It was part of the largest revision of food safety since the 1930s. FSMA is implemented by the FDA and relevant state agencies. It includes the authority to establish food safety requirements for farms producing fruits and vegetables, and for other participants across the food supply chain. The idea was to create a uniform minimum standard of food safety that the overwhelming majority of fresh produce growers must adhere to. And it shifted the focus of food safety from detection of food safety issues to prevention.
The rulemaking and public comment process was extensive, but beginning in 2017 the rules began being put into effect. The FSMA Preventive Controls for Human Food Rule governs food processing operations, which can include farms depending on the degree of value-added processing they are doing. The one most relevant for produce growers is the FSMA Produce Safety Rule, which sets food safety standards for farms to follow in an effort to minimize the risks of microbiological contamination that may occur during the growing, harvesting, packing, and holding of fresh produce. The first round of compliance dates for the Produce Safety Rule was at the end of January 2018. These two rules are among seven major rules that span across the supply chain, from farms to transportation to processing to imports.
2 | The Laws that Govern
One of the first challenges that growers will face with addressing FSMA is understanding the regulations that will implement the act in its aim to control common routes of contamination, including: agricultural water; biological soil amendments of animal origin; worker health and hygiene; equipment, tools, buildings and sanitation; domesticated and wild animals; and conditions for growing, harvesting, packing and holding activities. These include preventive controls, specific requirements for imported foods, food safety inspections, the sanitary transportation of foods, and food compliance timelines. Businesses will need to develop the necessary compliance items of FSMA rules, including log books for food handling practices.
In writing the FSMA, Congress recognized that different scales of farming and different types of supply chains pose different risks to the safety of the food supply. The risk-based approach that the FDA is implementing has flexibility in that some foods are excluded from the law (those rarely consumed raw, primarily); some producers may be exempt from all requirements; and some producers may be eligible for modified requirements. Concerning the latter group, FDA calls these producers “qualified exempt,” meaning their compliance is less burdensome, e.g., they operate under a set of modified requirements instead of the full set of Produce Safety Rules.
Timeline
The rules went into effect 60 days after the publication date in the Federal Register (November 27, 2015), but will affect businesses and farms at different times, depending on their operation size and the specific provision. The Produce Safety Rule which affects most produce (excluding sprouts and standards related to agricultural water quality), the dates for implementation are depending on size are
Good Agricultural and Handling Practices
Good Agricultural Practices (GAP) and Good Handling Practices (GHP) are voluntary audits that verify that fruits and vegetables are produced, packed, handled, and stored as safely as possible to minimize risks of microbial food safety hazards. Within the concept of GAPs, there are different certification agencies, private companies, and organizations, each offering their own requirements. Examples include GroupGAP and Harmonized GAP, two food safety programs under the USDA Agricultural Marketing Service, and several that are operated by either private companies or organizations, among them Primus GAP, GLOBALG.A.P., SQF Institute, and BRC Global Standards. Retailers or processors may not accept your product(s) unless you are GAP certified and have passed the program’s audit, which would consist of such things as keeping appropriate records, developing required plans, and performing needed tests such as those involving water quality.
Requiring a GAP certification is a decision made by the buying company, and it is entirely their choice. You
The Laws that Govern | 2

might think of it like this: GAP is a voluntary food safety program driven by buyers, whereas FSMA is law. So, even if a farm is FSMA compliant, it may still need to be certified under one or more GAPs to sell to certain buyers. The FSMA and GAP programs have many similar requirements since the overall aim is the prevention of food safety issues, but there will be differences, too. Ag producers will have to make a management decision regarding the volume of produce they may wish to sell and the cost of complying with a GAP brand and FSMA requirements.
NATIONAL ORGANIC PROGRAM
Consumer demand and premium prices have sparked interest in organic, so the USDA created the National Organic Program to make sure that products labeled as organic comply with set standards. Organic certification is voluntary and allows a farm or processing facility to sell, label, and represent their products as organic. A company can begin the process of certification by creating an Organic System Plan, which explains how the organization plans to comply with organic production requirements. The document should cover production and handling practices, inputs, monitoring, records, and procedures to prevent comingling with conventional produce or contact with prohibited substances. Once a company completes its Organic System Plan, it must submit the plan to a certifier. The certifier will review the plan, and then there will be an inspection to verify com
pliance. The inspection report will be reviewed by the certifier, and then a certification decision will be made.
Paperwork plays a major role in the organic world because products must be able to be tracked to verify that they are indeed organic.
WYOMING FOOD LAWS
In 2015, the Wyoming State Legislature passed the Wyoming Food Freedom Act (House Bill 0056), which became effective March 3, 2015. It was an aggressive revision of the state laws that govern food safety in Wyoming, and the aim was to allow food processors to sell directly to consumers. The act allows for the sale and consumption of homemade foods, and it encourages the expansion of agricultural sales at farmers’ markets and by ranches, farms, and home-based producers. The Food Freedom Act applies to food sales that take place directly between producer and consumer, and products must be purchased for home consumption.
In accordance with the act and revisions in 2017, food producers are legally allowed to sell the following foods directly to consumers:
Wyoming Food Freedom Act products cannot contain non-poultry meat (e.g., beef, lamb, pork, goat, seafood).













4 | The Laws that Govern
All meat (other than domestic rabbit, fish and poultry produced under the 1,000 bird limit) must come from a state or federally inspected facility.
Those businesses that sell Food Freedom Act-approved products can also sell inspected food as long as the facility is located at the ranch, farm, or home where the unregulated food is produced. The “retail space” where the unregulated food is sold must be physically separated from the area of the facility where the inspected food is sold with a “separate door and separate cash register or point of sale.” There must also be separation of coolers, freezers, and warehouse or other storage areas to prevent the commingling of inspected and uninspected products. Signage is required to indicate what sections of the store are offering inspected items for sale and which sections are offering uninspected items for sale.
Although there are no labeling requirements, producers must inform each customer that the product is not certified, labeled, licensed, inspected, or regulated. In addition, the law prevents any state governmental agency
from restricting the business, which means Food Freedom producers do not need a business license, are not subject to inspection, and no training is needed if the product(s) meets requirements of the Wyoming Food Freedom Act.
Wyoming Food Freedom Act products cannot be sold to wholesalers, brokers, or distributors, and sales outside of the state are prohibited. While producers can advertise products on the Internet and take orders and money over the Internet, they cannot ship products by mail or a courier service to consumers.
Wyoming Food Safety Rule
The Wyoming Food Safety Rule details the basic requirements for a food service establishment license. This applies to people processing, distributing, storing, or preparing food for wholesale or retail. It covers such topics as food care, labeling, personal hygiene, equipment and utensils, Hazard Analysis and Critical Control Points (HACCP), and egg grading, among others.
The Laws that Govern | 4


Business Considerations
FORMS OF BUSINESS ORGANIZATION
A business venture can generally be structured into one of numerous forms of ownership: the sole proprietorship, the partnership, the corporation, the limited liability company (LLC), the cooperative, or the nonprofit. All businesses must adopt some legal configuration that defines the rights and liabilities of participants in the business’s ownership, control, personal liability, life span, and financial structure. In making a choice, take into account the following considerations from the Small Business Administration’s Small Business Planner: Choose a Structure publication:
Sole Proprietorship
A sole proprietorship is a business owned by only one person. Sole proprietorships are easy to set up and are the least costly of the forms of ownership. A downside is that the owner faces unlimited liability, meaning that if the business cannot pay its debts, the creditors of the business seek to be paid using the personal assets of the owner. The vast majority of small businesses start out as sole proprietorships.
Partnership
A partnership is a business owned by two or more people who contribute resources (money, skills or knowledge, effort, etc.) into the entity. The partners divide the profits of the business among themselves – the profits from the business flow directly through to the partners’ personal tax return. In general partnerships, all partners have unlimited liability. In limited partnerships, the liability is limited to the extent of the owner’s investment.
Corporation
A corporation is a business organization that has a separate legal entity, separate from those who own it. Ownership in a stock corporation is represented by shares of stock. The owners (stockholders) are protected by having
Business Considerations | 6
limited liability, but have limited involvement in the company’s operations. The board of directors, a group elected by the stockholders, oversee the major policies and decisions of the corporation. The corporation has a life of its own and does not dissolve when ownership changes.
Limited Liability Company
Limited liability companies (LLCs) are hybrid forms of business that have characteristics of both a corporation and a partnership. An LLC is not incorporated, hence it is not considered a corporation. Nonetheless, the owners enjoy limited liability like in a corporation. An LLC may elect to be taxed as a sole proprietorship, a partnership, or a corporation. Overall, LLCs tend to provide the limited liability features of a corporation and the tax efficiencies and operational flexibility of a partnership.
Cooperative
A cooperative is a business organization owned by a group of individuals and is operated for their mutual benefit. The people making up the group are called
members. Cooperatives may be incorporated or unincorporated. Some examples of cooperatives are water and electricity (utility) cooperatives, agricultural cooperatives, purchasing cooperatives, credit unions, and housing cooperatives. In agriculture, cooperatives traditionally pooled raw goods such as grain and wool and sold them to an intermediary for further processing, or they were groups of growers who purchased supplies in bulk for use by the members. New generation cooperatives have offered value-added products themselves, such as meat products (as opposed to live animals), processed foods, bio-fuels and so on.
Nonprofit Corporation
If the venture has a goal other than providing profit to an individual, then organization as a nonprofit may be appealing. Nonprofits provide a public benefit, and are often religious, charitable or educational in nature. Nonprofits are allowed to make money – they just have to use those profits to further the organization’s public purpose. Nonprofits are organized at the state level, and then can apply for tax-exempt status at the state and national levels (with the IRS). At the national level, several types of nonprofits are available that have different eligibility requirements and allow for different types of activities, for instance 501(c)(3) nonprofits advocate for a charitable purpose and cannot engage in legislative lobbying or political campaigning, but contributions to them are usually tax deductible, while 501(c)(4) nonprofits promote social welfare and can lobby and campaign, but donors cannot claim their contributions as tax deductions. Starting a nonprofit is fairly easy, and may open some sources of funding that for-profit ventures can’t access.
BUSINESS LICENSING
Farm and food businesses are subject to business licensing and permitting requirements at the federal, state, and local levels.
Federal Government
For information on specific federal licenses that a business might need, refer to the Small Business Administration’s Business Guide at www.sba.gov/content/obtaining-business-licenses-permits.
8 | Business Considerations

The USDA issues permits for businesses involved in the importation and interstate transportation of animals, animal products, biologics, biotechnology, and plants. For more information on these permits, visit www.aphis.usda.gov/permits
State of Wyoming
Most states impose license fees or taxes on a wide range of businesses, occupations, and professions, ranging from nominal to substantial amounts, depending on the activities. And the license or permit may be granted based on a combination of requirements such as registration, bonding, education, experience, and passage of licensing exams.
Every business has unique needs, so business owners are encouraged to consult with the Wyoming Department of Agriculture for assistance with specific food industry permit requirements. For instance, these licenses may be relevant to small food and farm businesses involved in food processing, food distribution, food storage, and food preparation; those involved in wholesaling or retailing food; dairy product production; fruit and vegetable handlers; those who offer food samples; plant and nursery producers; pesticide applicators; meat and poultry handlers; apiary operators; those who grade eggs; and others. Note also that a license is needed for scales used in the weighing of food. But if the food produced is sold to an informed end consumer, then it is exempt from licensing under the Wyoming Food Freedom Act.
Wyoming Counties
Many counties and municipalities in Wyoming also have zoning and licensing requirements for farm and food businesses. As of 2018, five Wyoming counties and one city provide their own local food inspection services and enforce standards that are equal to or stricter that the state standards: the City of Laramie, and the counties of Laramie (Cheyenne), Natrona (Casper), Sweetwater, Sublette, and Teton. The Wyoming Department of Agriculture can provide the appropriate county or local contact to determine local business licensing and permitting requirements. If there is no county/city health inspector, then the responsible agency will be the Wyoming Department of Agriculture.
Common licenses issued at the county level include:
TAXES
Federal Taxes
It is important for small businesses to understand federal tax obligations, including individual or business income tax, employee income tax withholding, and whether the small business must acquire an Employer Identification Number (EIN), also known as a federal tax identification number.
For an in-depth paper on federal farm tax management, see the Small Farm Tax Guide, available online at www.ruraltax.org/small-farm-tax-guide.
The Internal Revenue Service (IRS) offers many tax publications for guidance, including Publication 225, the Farmer’s Tax Guide, available at www.irs.gov/pub/irs-pdf/p225.pdf. This guide can help producers determine whether to file Schedule C (“Profit or Loss From Business [Sole Proprietorship]”) or Schedule F (“Profit or Loss From Farming”).
To determine whether a farm or food business should apply for an EIN, check with the IRS. Generally, the business should have an EIN if it does any one of the following:
Business Considerations | 8
Additionally, a business owner should contact the business licensing agency in Wyoming to determine whether the business requires a state number or charter. The Wyoming Department of Agriculture and some local jurisdictions license food manufacturers, wholesalers, and retailers. wyagric.state.wy.us/divisions/chs
State and local sales and property taxes may also be required. The section below provides additional information on these topics.
Wyoming Taxes
Under Wyoming law, there are many tax obligations for a small business. This guide only includes details about those that are relevant to small food and farm businesses. For additional information, contact the Wyoming Secretary of State’s Office or the county tax assessor’s office in the county where the farm or food business is located.
Relevant taxes include: sales and use tax, federal withholding tax, and county property taxes.
Sales and Use Tax
Food businesses that sell value-added goods are required to register and obtain a state sales and use tax identifi
cation with the Wyoming Department of Revenue. In 2018, the fee was $60.
Taxes must be assessed on goods sold at retail outlets. Food products are subject to a 4% sales tax throughout the state, as levied by the State of Wyoming; however, some products are not taxable or are exempt from taxation. Food for domestic home consumption was made exempt in 2007, including substances in liquid, concentrated, solid, frozen, dried, or dehydrated form that are sold for ingestion or chewing by humans and are consumed for their taste or nutritional value (according to the Wyoming Department of Revenue). It does not include alcoholic beverages, tobacco, or prepared foods. So donuts and cookies are food, but not “prepared food”—and thus aren’t taxable. Deli meat and bread bought individually at a supermarket are also not taxable, but a sandwich from the deli counter is. Soft drinks are tax-free, unless they’re sold for immediate consumption. Eggs aren’t prepared food, and neither is frozen pizza.
Agricultural producers can obtain an exemption from paying tax on fuel used in (non-highway) agriculture (dyed diesel, which is regular diesel fuel that has a dye to identify the fuel as non-taxed)—and sales by religious and charitable organizations are also exempt. Also, the tax can be refunded for non-highway use of undyed diesel.
For other products, there is a range of sales tax rates by county. Depending on local municipalities, the tax may be as high as 6%.
10 | Business Considerations

For those registering for a sales tax permit, Wyoming assigns a filing frequency based on the amount of sales tax the applicant collects in the state. Taxes collected can be remitted electronically or manually on a monthly basis (if more than $150 is collected), quarterly (if the collection is between $50 and $150), or annually (less than $50). Sales tax returns are almost always due the last day of the month following the reporting period.
The Wyoming Department of Revenue provides information on tax issues at revenue.wyo.gov/Excise-Tax-Division.
Withholding Tax
Small businesses having employees who work in Wyoming are not required to withhold state income tax on their wages since Wyoming has no state income tax; however, federal income tax must be withheld from employee wages and remitted to the IRS. Every employer must file for a withholding tax number.
Wyoming Workers’ Compensation Law
Workers’ compensation is a compulsory form of insurance that provides benefits to workers for covered injuries through a state-run program. The employer pays a premium to the state, and the state pays for the costs of injuries. The employer gets immunity from civil lawsuits for damages filed by their workers for injuries suffered in the workplace, but employers are responsible for paying injured workers statutory benefits that are less expensive (from the perspective of the employer) than court damages but are (from the perspective of the worker) more certain and swiftly provided. Employers are also required to pay for reasonably necessary medical expenses related to work-related injuries. In many states (including Wyoming), employers also pay for the cost of vocationally rehabilitating injured workers. In general, an employee with a work-related illness or injury can get workers’ compensation benefits regardless of who was at fault—the employee, the employer, a coworker, a customer, or some other third party. Most employers are required to have workers’ compensation coverage and, as in other states, many employers prefer workers’ compensation coverage to the potential for significant liability from judgments in civil lawsuits. Those exempted from having coverage are very small employers and a very few specific
types of employers, typically in the agricultural sector, and domestic employees. www.wyomingworkforce.org/businesses/workerscomp.
Property Tax
County tax assessor’s offices contact businesses regarding taxes on real property held by an individual or the business, usually by a bill mailed to the owner of record. The office will classify the land as to its purpose, whether residential, business, commercial, or agricultural. Many states, including Wyoming, have laws regarding the preferential assessment of agricultural land, in which the land’s value is assessed based on its current use rather than its highest and best use. Thus, the county assessor may require information from the property owner concerning identifying the property (its boundaries) and real property improvements such as the addition of a new structure, which would affect the value of the property.
ZONING
Zoning authority, which is granted by the State of Wyoming, allows local jurisdictions to manage where different types of land uses and buildings are located in the city. It also allows the city to control the density of development and types, sizes, and setbacks of buildings.
Generally, zoning controls are intended to:
Each city (or county) will define the districts with controls restricting the use of the land for each (which are defined in the ordinances or municipal code). Common categories include agricultural, rural residential, suburban residential, manufactured home, commercial, or industrial. There may be different grades within each district, such as light versus heavy industrial, or rural residential with a minimum size of, say, 35 acres (very low density) versus five acres (low density).
Business Considerations | 10


General Requirements
INSPECTION
Regardless of which agency has jurisdiction, the legal basis for agency oversight is the state and/or federal constitutional authority to protect public health and safety. Whether the requirements are imposed by federal, state, or local authority, the relevant laws focus on the safe and wholesome production of food and the adequacy and integrity of information provided to consumers. For this reason, the process of preparing and selling food to the public begins with an inspection for those selling at the retail or wholesale level. As noted before, if the food produced is sold to an informed end consumer, then it is exempt from licensing, inspection, and labeling under the Wyoming Food Freedom Act.
The inspection may be conducted by the Wyoming Department of Agriculture’s Consumer Health Services Division (or city or county-based health department) after an application. See wyagric.state.wy.us/divisions/chs/food-safety for full details of establishing a food business.
The inspection is based on Good Manufacturing Practices developed by the FDA and set forth in federal regulations (these are discussed in more detail in a later section of the publication). The inspection will focus on the food preparation area and other areas where processing and packaging of food take place, but may include other areas in which ingredients and equipment are stored. The inspection is required to ensure that the processing area is clean; is free of insects, rodents, and pests; and has no sanitation or safety concerns. Home-based kitchens under the Wyoming Food Freedom Act are not regulated.
Key requirements of inspected kitchens are:
HIGH-RISK AND LOW-RISK FOODS
Most food poisoning is caused by bacteria (although it can also be caused by viruses, parasites, and toxins (or poisons) produced by certain kinds of bacteria, and chemicals that may get into food). And all foods can cause food poisoning if they aren’t properly handled. Common symptoms of foodborne diseases are nausea, vomiting, stomach cramps, and diarrhea; however, symptoms can sometimes be severe, and some foodborne illnesses can even be life-threatening and cause death. For instance, the bacterium known as Clostridium botulinum grows in sealed environments without oxygen and produces a deadly toxin. If the toxin is ingested, the consumer may suffer from botulism, which can be fatal.
And bacteria grow better in some foods than others. From the food processor’s perspective, high-risk foods are those having ideal conditions for bacteria growth.
General Requirements | 12

Typically these are:
Disease-causing bacteria grow particularly well in foods high in protein such as meats, poultry, seafood, eggs, dairy, cooked vegetables such as beans, and cooked cereal grains such as rice. Because of the high potential for rapid bacterial growth in these foods, they are known as “potentially hazardous foods.” Generally, high-risk foods are any ready-to-eat products that will support the growth of pathogenic bacteria easily and do not require any further heat treatment or cooking. Potentially hazardous foods include:
The way to reduce the risk is to use temperature controls to minimize the potential for harmful bacterial growth in foods (such as in cold holding, during thawing, in cooking, hot holding, and during cooling and reheating). Many other factors come into play, as well, including proper sanitation involving both facilities and workers, proper pest control, etc.
Low-risk foods are those that do NOT have good conditions for bacteria growth. Foods that are low-risk (or “non-potentially hazardous”) means any food that does not require temperature or time control (time control meaning the amount of time a refrigerated item is out of refrigeration) for safety to limit pathogenic microorganism growth or toxin formation. The natural pH or the final pH of the acidified food must be 4.6 or less. These foods include:
What’s a low-acid food?
Low-acid foods have a pH level greater than 4.6, which means they are not acidic enough to prevent the growth of C. botulinum bacteria. Examples are:
*Tomatoes require added acid—lemon juice or citric acid—for safe home canning.
pH is the measurement of the acidity or alkalinity of a solution commonly measured on a scale of 0 to 14—pH 7 is considered neutral, with lower pH values being acidic and higher values being alkaline or caustic. pH is the most common of all analytical measurements in industrial processing.

14 | General Requirements
Low-risk foods generally don’t need to be refrigerated (until opened) and tend to be high in sugar, salt or acid and/or low in water content. Low-risk foods most often spoil due to their chemical composition (not microbiological activity) and usually have a “best before” date. Examples of low-risk foods include:
Classification
Since acid is such an important indicator of safety in industrial processes, from the regulatory point of view, foods are classed as acid, low acid, or acidified depending on the natural acidity of each product. The pH value of 4.6 is important because it is the point at which C. botulinum produces the potent toxin that causes the potentially lethal disease botulism. The regulations concerning acidified foods were aimed at limiting C. botulinum through acidification and pH control since this microorganism is very heat resistant (it is not destroyed by pasteurization or cooking temperatures below 212°F).
A product’s acidity is measured based on a pH scale. If the raw or initial product has a pH above 4.6 it is considered a low-acid food. Naturally acid foods have a naturally-occurring pH of below 4.6. Most pathogenic microorganisms will not grow or reproduce in an environment with this level of acidity.
Acidified foods are low-acid foods to which acids are added to produce a final equilibrium pH of 4.6 or below. Examples of acidified foods include pickled vegetables and eggs. Low-acid canned foods are defined as foods that undergo a thermal process prior to being placed in a hermetically-sealed (airtight) container. Examples of low-acid canned foods include canned beans or peas.
General Requirements | 14

GOOD MANUFACTURING PRACTICES
All inspected food processors in Wyoming, without exemption, are required to comply with Good Manufacturing Practices as set forth in federal regulations. These regulations specify that the premises on which the food is prepared be maintained to prevent contamination of food by, for example: (1) eliminating conditions that would provide breeding grounds for pests; (2) properly maintaining waste treatment and disposal facilities;(3) using protective coverings; (4) providing adequate lighting in hand-washing and food-preparation areas; (5) providing adequate ventilation; and (6) properly cleaning, sanitizing, and maintaining equipment. The law, 21 CFR Part 117, is the part of Title 21 of the Code of Federal Regulations that establishes FDA regulations for Good Manufacturing Practices for Human Food. It consists of nine sections:
1.Personnel §117.10
2.Plant and grounds §117.20
3.Sanitary operations §117.35
4.Sanitary facilities and controls §117.37
5.Equipment and utensils §117.40
6.Processes and controls §117.80
7.Warehousing and distribution §117.93
8.Holding and distribution of human food by-products for use as animal food §117.95
9.Defect action levels §117.110
The full text of the current version of Good Manufacturing Practices is available online by doing an Internet search for “21 CFR Part 117”.
PRODUCTION IN HOME KITCHENS
Wyoming law authorizes the production of foods in home kitchens. The production area of those producers making foods under the Wyoming Food Freedom Act are not subject to an inspection to protect public health, and are exempt from state licensure, permitting, packaging, and labeling requirements, and no training is required. The foods produced can only be sold to an informed end consumer directly for home consump


16 | General Requirements
tion. “Informed end consumer” means he or she has been informed that the food producer is not licensed, regulated, or inspected.
MOBILE KITCHENS
Mobile food units and pushcarts are subject to regulation and inspection by the health department in the county/city in which the unit is located (or the state if there is no local department). All mobile food units are required to have a permitted restaurant or commissary as a base of operations if the unit does not meet all requirements to be self-contained. The base facilities (commissary) must have a potable and protected source of water and adequate facilities for the disposal of solid waste, and they must meet requirements to clean and sanitize equipment, storage of food and other supplies. Home kitchens are not allowed as a commissary. The units and pushcarts must be kept clean and sanitary, and may not be operated by anyone with a communicable illness that can be transmitted by food. If the unit is self-contained and meets requirements of the Wyoming Food Safety Rule they can be issued a yearly food license. If the unit and pushcart cannot meet these requirements then the operator must get a temporary food license for each event attended.
LABELING AND PACKAGING
Lawmakers and administrative agencies have developed specific requirements for information that must be presented on all labels, an effort designed to ensure that consumers have adequate information to help them make informed decisions. But most laws governing labeling, claims, and marketing of food apply to processed and packaged foods rather than raw agricultural products, unless prepackaged for retail sale. Concerns about the safety of food additives, color additives, adulterants, misleading or misbranded labels, and lists of ingredients, allergens and nutritional claims evolved with the increased processing, packaging, and national distribution of foods (and related outbreaks of illness such as botulism, increases in cancer linked to food additives, and deaths from harmful substances in foods and drugs), and a lengthy patchwork of laws and regulations was developed in response.
Many of these requirements are not applicable to raw or whole foods, which are readily identifiable and can be
General Requirements | 16

visually inspected by the consumer prior to purchase, unless prepackaged. It also is assumed that the consumer will properly wash and prepare many raw foods prior to consumption. Consequently, this section focuses on general labeling and packaging requirements for raw agricultural products and their sale as whole or minimally processed food to the consumer or other end-user. Information specific to particular food products (e.g., meat, eggs) is below.
Federal Guidance
The FDA is responsible for assuring that foods sold in the United States are safe, wholesome, sanitary, and properly labeled. The Federal Food, Drug, and Cosmetic Act of 1938 and the Fair Packaging and Labeling Act of 1967 are the federal laws governing food products under FDA’s jurisdiction. The FDA published a guide to assist producers in navigating the complex rules that govern food labeling requirements. To easily find the guide, do an Internet search for “FDA” and “Guidance for Industry: A Food Labeling Guide”.
Misbranding
A food is considered to be misbranded if its labeling is found to be “false or misleading in any particular.” Food packaging and labeling must accurately convey the product’s identity and source of manufacture. Civil fines may be levied.
Adulteration
A food will be considered adulterated if it contains any poisonous or deleterious substances, such as chemical contaminants, metals, or filth, which could render it harmful to health.
Allergen Labeling
In 2004, Congress passed the Food Allergen Labeling and Consumer Protection Act, which requires food manufacturers to label products containing eight major allergens: milk, eggs, wheat, fish, shellfish, tree nuts, peanuts, and soy. The law requires that the common or usual name for each of the allergens be listed in the ingredients or in a separate statement starting with “Contains…”
The FDA takes allergen labeling very seriously. Recent FDA warning letters to food manufacturers involve allergen labeling errors, commonly associated with seafood and bakery products. If the product’s allergens
are not labeled, the FDA considers the product “misbranded,” one of the two big violations of FDA law along with “adulteration.” Misbranding can result in warnings, costly product recalls, and, over time, even fines and imprisonment. Including the ingredient(s) in the product title (e.g., peanut butter) does not satisfy the regulatory requirements.
WYOMING LABELING REQUIREMENTS
Wyoming’s state statues address food labeling in line with federal regulations. For foods produced under the Wyoming Food Freedom Act, there are no labeling requirements, but producers must inform each customer that the product is not certified, labeled, licensed, inspected, or regulated. No specific method of informing the consumer is identified in the Food Freedom statute, but farmers’ market vendors (or vendors at ranch, farm or home) often post signs saying that the food is produced under the Wyoming Food Freedom Act and is not certified, labeled, licensed, packaged, regulated or inspected, or they inform the customer orally.
SAMPLING
Offering samples can help to promote products of the farm or garden, and Wyoming state law allows for vendors to offer free samples of their food products. A sampling permit required by the Wyoming Department of Agriculture is good for 14 nonconsecutive days (enough for a farmers’ market season). If a produce vendor is offering free samples such as whole fruit or vegetables, the producer is exempt from a sampling license. If the vendor is cutting, slicing, etc., then a sampling permit is required. This includes meeting the requirement of a temporary food stand to maintain proper sanitation requirements.
If the sampled food is produced under the Wyoming Food Freedom Act, then the producer is exempt from the requirement of a sampling license.
Foodborne illness outbreaks can happen anywhere and can affect a large number of people, so please follow safe food handling guidelines to minimize the risk of foodborne illness.

18 | General Requirements

General Requirements | 18


Meat and Poultry Products
Meat is defined as beef, lamb, pork, and goat. Poultry is defined as domestic chickens, turkeys, ducks, geese, guineas, ratites, and squabs. Laws and regulations governing meat and poultry do not apply to fish.
All meat sold to the public or to a licensed food business must come from a state or federally inspected facility. And wild game, such as deer, antelope, elk, cannot be sold unless butchered at an inspected facility.
Wyoming statute defines an exotic animal as reindeer, elk, deer, antelope, water buffalo or bison, The same is true of wild game birds.
Even under the Wyoming Food Freedom Act meat products – including wild game and birds – cannot be sold, but home-processed domestic rabbit meat, poultry produced under the USDA 1,000 bird small producer exemption (which are raised and processed on the producer’s operation), and fish (except catfish) can be sold to the end consumer.
FEDERAL REQUIREMENTS
In order to sell meat and poultry (unless under the poultry exemption)—whether through large grocery stores or co-ops, at farmers’ markets, through Community Supported Agriculture [CSA] ventures, or on-farm directly to consumers—the meat must be processed at a facility that has been inspected by either federal or state officials. The Federal Meat Inspection Act of 1906 gives the USDA the authority to inspect animals and butchered meats intended for interstate commerce or export. Meat that is inspected by a state official (i.e., in a state-inspected facility) rather than a USDA official (i.e., in a federally inspected facility) may be sold intrastate, but may not be shipped across state lines. This restriction to intrastate commerce means that the meat may not be sold online to out-of-state customers, by mail-order to out-of-state customers, or in any way shipped out of state.
The Federal Meat Inspection Act requires animals to be inspected prior to slaughter. Any animal that is diseased or ill must be slaughtered separately and closely examined. Humane methods of slaughter must be employed, and the agency is authorized to suspend operations at any facility that fails to comply with the requirements of the Humane Methods of Slaughter Act of 1958. The carcasses and parts may not be further processed for sale to the public until they (1) pass inspection; (2) are labeled or marked as “inspected and passed” by the inspector; and (3) are labeled to identify the kind of animal from which they were derived and the facility at which they were processed. Any parts determined to be adulterated must be marked “inspected and condemned,” and the condemned parts must be destroyed.
Before meat may be sold, it must be inspected, properly marked, and labeled. In accordance with federal and state requirements, all meats offered for sale to the public must be labeled with the following information:
Meat and Poultry Products | 20
The name and address of the farm may be included on the processor’s label, or may be added as a separate label as long as it does not obscure any part of the processor’s label. A label indicating the sale price may also be added as long as it does not obscure the processor’s label. Labels must be approved by the USDA or state inspection office prior to use. The producer is encouraged to work directly with the processor to prepare a custom label if one is desired for marketing purposes. A custom label may include other claims, such as “certified organic” or “grass-fed,” as long as those claims meet the standards, certification, or other requirements of the relevant laws governing product information. Note, if the animal is raised as “certified organic,” then in order to label the final product as such, the processing facility must also be certified organic. All labels must be approved and affixed at the plant the product was processed. A producer cannot affix any other labels to the product after it leaves the processing plant.
In an effort to prevent false or misleading food labeling and advertising, government agencies have defined and restricted the use of certain words and phrases that consumers rely on in making decisions about which foods to purchase. For example, the USDA Agricultural Marketing Service established a voluntary standard for a “grass-fed” ruminant livestock marketing claim. To qualify for use of this claim, the animal’s diet must be derived solely from forage consisting of grass (annual and perennial), forbs (e.g., legumes, Brassica), browse, or cereal grain crops in the vegetative (pre-grain) state. Animals cannot be fed grain (such as corn) or grain byproducts and must have continuous access to pasture during the growing season. The producer may ask the Agricultural Marketing Service to verify the claim through an audit of the production process. To qualify, the producer must be able to verify that the standard’s requirements are being met through a documented quality management system.
ORGANIC LABELING
To label meat as certified organic, the ranch or small-scale operation on which the animal was raised must
be certified as an organic operation with respect to the livestock produced on it. The animals’ feed must be certified organic, and may not contain plastic pellets for roughage, manure refeeding, or formulas containing urea. In addition, the livestock may not be given growth promoters or hormones, whether implanted, ingested, or injected, including antibiotics and synthetic trace elements used to stimulate growth or production. In addition, the farmer may not use subtherapeutic doses of antibiotics, synthetic internal parasiticides on a routine basis, or administer medication—other than vaccinations—in the absence of illness. The processing plant must also be certified organic to be labeled as such.
NUTRITIONAL LABELING
The USDA’s Food Safety Inspection Service requires single-ingredient retail cuts of meats to be labeled with nutritional information. Alternatively, nutritional information must be displayed at the point of sale.
WYOMING RULES
Meat and meat products sold in intrastate commerce (within the state) are regulated by the Wyoming Department of Agriculture’s Consumer Health Services. The agency has adopted by reference the federal requirements for inspection as described above. Even though there are few, if any, differences between a federally and state-inspected facility, meat from animals slaughtered and/or processed in a state-inspected facility may not be sold in interstate commerce.
Meat that has been inspected at a state or federally inspected facility may be sold to grocery stores, restaurants, and institutions (such as schools and prisons). These food establishments may set their own requirements—i.e., specify whether they require meat to be processed in a state or a federally inspected facility, whether they require proof of liability insurance (proof of liability insurance is not a requirement of the Wyoming Department of Agriculture), and how they want their meats packaged and labeled—to satisfy their own or their customers’ needs. Meat may be sold fresh or frozen.
Homemade products containing meat or wild game would not be allowed under the Wyoming Food Freedom Act – those products would have to be processed or sold under inspection. However, home-processed do
22 | Meat and Poultry Products

Meat and Poultry Products | 22
mestic rabbit meat, poultry produced under the USDA 1,000 bird small producer exemption (which are raised and processed on the producer’s operation) and fish (except catfish) are allowed to be sold, but only directly to the final informed end consumer.
Custom-Exempt Slaughter
Custom slaughter facilities serve farmers, ranchers, and customers who want their meat butchered and processed for personal use or for those who purchase a live animal and who want an animal slaughtered or processed for their own personal consumption. (Customers must first own the animal before it goes to processing, and the owner does not have to be the farmer or rancher). A beef steer, for example, could be sold as quarters to four different customers with proper record-keeping and documentation that the animal was spoken for prior to slaughter. Applicable animals such as beef must have a brand inspection from the Wyoming Livestock Board prior to slaughter.
While the facilities are periodically inspected for sanitation, animals processed at these facilities are not inspected for disease. Custom exempt processors must still meet state and federal plant guidelines for sanitation and construction, but are inspected less frequently than continuously inspected USDA or equal-to plants. The meat is cut, packaged, and labeled “Not for Sale” before being returned to the owner of the animal. To learn more about the three categories of meat plants (state inspected, custom exempt, and wild game) do an Internet search for “Wyoming Department of Agriculture” and “State Meat Program.”
Although overseen by the same regulatory agency, the requirements for meat and meat products differ from those for poultry and poultry products. Wyoming does not allow the on-farm slaughter or processing of meat for sale. On-farm custom slaughter and processing is allowed, but only if the meat is used for personal consumption, or for consumption by one’s family, employees, or invited, non-paying guests.
State law prohibits a farmer from selling an animal (or shares or interests in an animal) that would then be butchered on-site and packaged for off-farm use. While producers may not slaughter and process their animals on-site and sell the products to consumers, they may take

the animals to a processor who is licensed and inspected by the state. Once the animals are inspected, butchered, and packaged, the packages are marked with the Wyoming State Inspection legend. At this point, the producers can sell the packaged meat at an on-farm or ranch store or at a local farmers’ market.

Grade A Dairy
Federal and state-specific requirements for dairy marketing and labeling are outlined below.
FEDERAL REQUIREMENTS
Milk Ordinance and Pasteurization
The FDA is responsible for the enforcement of milk sanitation standards on interstate carriers, as well as milk and milk products shipped in interstate commerce. The FDA requires all milk sold in interstate commerce to comply with the Pasteurized Milk Ordinance (sometimes referred to as the Grade “A” Pasteurized Milk Ordinance). Further, the FDA prohibits the introduction into interstate commerce of any unpasteurized milk product intended for human consumption. The milk ordinance applies to milk produced by lactating cows, goats, sheep, water buffalo, and other hooved mammals.
The Pasteurized Milk Ordinance was first adopted in 1938, when milk-borne outbreaks constituted 25% of all disease outbreaks due to infected foods and contaminated water. By contrast, fluid milk products currently are associated with less than 1% of such reported outbreaks. The FDA maintains that “raw milk, no matter how carefully produced, may be unsafe.” Some states permit the intrastate sale (within the state) of raw milk intended for human consumption, and Wyoming does too under the Wyoming Food Freedom Act.
The milk ordinance “incorporates the provisions governing the processing, packaging, and sale of Grade ‘A’ milk and milk products, including buttermilk and buttermilk products, whey and whey products, and condensed and dry milk products.” It sets forth permit and inspection requirements and enforcement standards; standards for pasteurization, processing and packaging; procedures for milk sampling, handling, and transportation; definitions of milk products; standards for dairy farm construction; standards for water sources; procedures for animal disease control; cleaning and sanitizing requirements; approved testing methods for chemical and bacteriological agents (including vitamins A and D content); tolerance levels for drug residues; and vitamin fortification, among other things.
The ordinance also sets forth requirements for maintaining the cowyard. The “cowyard” is defined to include “the enclosed or unenclosed area adjacent to the milking barn in which the lactating animals may congregate,” along with the animal housing areas and feedlots. These areas are required to be graded and drained, and depressions and soggy areas must be filled. These requirements are imposed to minimize soiling of the udders with manure and dirt and thus contamination of the milk.
The ordinance also addresses the health of the lactating animal, as some diseases of lactating animals can be passed through the milk and communicated to humans who consume it. In addition, antibiotics used to treat illness in lactating animals can be passed to the milk. For these reasons, lactating animals that are ill or being treated with antibiotics or other medicines must be milked separately and their milk safely discarded.
The Pasteurized Milk Ordinance also addresses labeling of milk and milk products. The label must contain the identity of the milk plant, the type of hooved animal that produced the milk (e.g., goat), and the words Grade “A.” Misleading labels and claims are prohibited (e.g., Select Grade “A”).
In addition to these labeling requirements, others may apply as well. For example, to label milk as organic, the dairy farm must be certified in accordance with requirements set forth by the National Organic Program. Specifically, the cow must not have been treated with antibiotics, hormones, or synthetic parasiticides, or given
Grade A Dairy | 24

any animal drug—other than vaccine—in the absence of illness.
One of the most controversial topics concerns labeling of milk from cows treated or not treated with a bovine growth hormone (e.g., recombinant bovine somatotropin [rBST]) since 1993, when the FDA first approved the use of rBST. Responding to concerns from consumers, the dairy industry, and states, the FDA published interim guidance on the labeling of milk and milk products from cows that have not been treated with rBST in 1994. The FDA expressed concern that labeling milk as rBST-free could be misleading, because no test could distinguish between milk from cows treated or not treated with rBST, and because there wasn’t any known compositional or health-related difference between milk from treated and untreated cows that would make one safer than the other. The FDA determined that to avoid misleading the public, labeling claims about the use of rBST should be placed in context and accompanied by a statement that “No significant difference has been shown between milk derived from rBST-treated and non-rBST-treated cows.” The ultimate decision about the exact wording of the label is relegated to the states, in accordance with requirements of the FDCA regarding misbranding by the use of false or misleading statements. States are encouraged to adopt the Pasteurized Milk Ordinance as a means of overcoming interstate trade barriers. When a state adopts the ordinance, its enforcement becomes a function of local or state authorities.
WYOMING RULES
Wyoming has adopted the Pasteurized Milk Ordinance. The state also has adopted strict laws and regulations to ensure the quality and safety of milk and milk products sold to the public. Pursuant to state law, dairy farms and milk plants are required to obtain a permit from the Wyoming Department of Agriculture’s Consumer Health Services. This permit covers the milk plant and plant-owned distributors. The department is authorized to inspect and sample any facility or container used in the production, testing, processing, and distribution of milk, cream, butter, cheese, ice cream, frozen dessert, or any dairy product for which standards of purity and identity
have been established. The Wyoming Department of Agriculture inspects dairies every six months.
It also requires the sampling of Grade “A” raw and pasteurized milk and milk products a minimum of four times every consecutive six months. If the Wyoming Department of Agriculture determines that the product has become harmful to the health of consumers at some point during production, processing, or distribution, or that the facility is in violation of its permit, the department may issue a “notice of intent to suspend license” to prohibit the product’s further processing, distribution, or sale and label the product accordingly. Regulatory sampling of raw milk is required for bacteria limits, drugs, and somatic cell counts. Water is also tested in Wyoming every six months for coliform. Pasteurized milk products are also tested for bacteria, coliform, phosphatase (which determines if a product was adequately pasteurized), and drugs. Details can be found in Grade “A” Pasteurized Milk Ordinance from the Wyoming Department of Agriculture.
Raw Milk
Wyoming allows the sale of raw milk for human consumption if sold directly to informed end consumers.
Before passage of the Wyoming Food Freedom Act, there was no exemption for on-farm sales, exchanges through barter, or through the sale of shares or interest in lactating animals (sometimes referred to as “cowshares”). Now the sale of raw milk and products made from it is allowed. No testing for brucellosis or other diseases is required, though it is advised. Inspected dairies are tested quarterly for brucellosis. Raw milk sold for non-human consumption, e.g., for animal feed, is also allowed.
26 | Grade A Dairy


Grade A Dairy | 26

Poultry
The production and processing of poultry and poultry products is governed by both federal and state law. Poultry includes chickens, turkeys, ducks, geese, guineas, and squabs.
FEDERAL POULTRY LAWS
As with meat and meat products, poultry and poultry products must be slaughtered and processed at a USDA-inspected facility to be sold in interstate commerce. The federal Poultry Products Inspection Act of 1957 sets forth requirements for poultry slaughtering facilities, and these requirements are implemented through regulations adopted by the USDA relating to eggs and poultry products.
The USDA is authorized to inspect poultry prior to slaughter, and it is directed to inspect each carcass while processing operations are being conducted. Any carcass or part deemed adulterated must be destroyed for human food purposes. Poultry to be processed in accordance with recognized religious dietary laws may be exempt from certain requirements.
WYOMING RULES
The Wyoming Food Rule governs the processing and sale of poultry and poultry products in this state. This law is administered by the Wyoming Department of Agriculture’s Consumer Health Services Division. Unlike meat and meat products, on-farm slaughtering and processing of poultry for sale is allowed, so long as it is processed under an exemption.
If the poultry and poultry products are to be sold in intrastate commerce, such as through a CSA, at a farmers’ market, or on-farm, the birds must be processed in either a state or federally inspected facility or under one of the poultry exemptions listed below. Poultry and poultry products are regulated by the Wyoming Department of Agriculture. The requirements are markedly similar to those set forth in federal law, as the state has adopted the relevant federal regulations by reference. Facilities that slaughter poultry or process poultry products solely for intrastate commerce are required to employ sanitary practices and properly maintain their premises, facilities, and equipment.
The Wyoming Department of Agriculture has the authority to inspect poultry and poultry products and regulate the processing and distribution of poultry in order to protect both public health and the economic vitality of the state’s poultry industry. This authority is vested through the Wyoming Meat and Poultry Inspection program, which is directed to inspect poultry, parts, and carcasses in each official establishment engaged in processing poultry or poultry products solely for intrastate commerce. Poultry products must pass inspection before they may be sold or transported in interstate commerce, and the blood, feathers, feet, head, and viscera must be removed prior to transport or sale.
Small-Scale Producer Exemption
There are exemptions for small-scale poultry producers. A farmer who slaughters and processes (on his premises) 1,000 poultry or less in a calendar year is exempt from the Poultry Products Inspection Act. This exemption is restricted to poultry a producer raises on his or her own farm. Slaughtering and processing are still required to be conducted using sanitary standards, practices and
Poultry | 28
procedures, and the grower must keep accurate and legible records, including the number of birds slaughtered and the sales to consumers. Such poultry products must be labeled with the processor’s name and address, safe handling instructions, and the statement “Exempt P.L. 90-492.” (P.L. stands for “Public Law”.) The Wyoming Food Safety Rule does not allow wholesaling of poultry under the exemption unless the producer meets regulatory facility requirements and is inspected. The Wyoming Department of Agriculture will also issue a state poultry exemption number to identify producers who are able to sell to hotels, restaurants, and institutions under the act.
A farmer who slaughters 20,000 poultry or less per calendar year may slaughter and process for retail sale on his own farm poultry that he has raised, as long as he provides the consumer with his name and address and the products are otherwise fit for human consumption when sold. These products may be sold on the farm, or directly to consumers, restaurants, and food service businesses where used to prepare meals for sales directly to consumers. This exemption applies only if the poultry products are to be sold in-state; they may not be shipped or transported for sale across state lines. Slaughtering and processing are still required to be conducted using sanitary standards, practices, and procedures, and the grower must keep accurate and legible records, including the number of birds slaughtered and the sales to consumers. Such poultry products must be labeled with the processor’s name and address, safe handling instructions, and the statement “Exempt – P.L. 90-492.” This is known as “Producers/Grower Exemption.”
The Wyoming Food Safety Rule does not allow wholesaling of poultry under the exemption unless the producer meets regulatory facility requirements and is inspected. The Wyoming Department of Agriculture will also issue a state poultry exemption number to identify producers who are able to sell to hotels, restaurants, and institutions under the act.
Slaughter for Personal Consumption
A farmer may slaughter and process on his own farm poultry that he has raised, but only if the poultry prod
ucts are to be used exclusively by members of his household and invited, non-paying guests.
Other Exemptions
Exemptions may also be available for poultry that is to be processed as required by certain religious dietary laws. In those instances, the poultry or poultry products must be identified with the name and address of the producer, and be sound, clean, and fit for human food when distributed.
Organic Labeling
To label poultry as certified organic, the farm on which the animal was raised must be certified as an organic farm with respect to the livestock produced on it. The animals’ feed must be 100% certified organic (e.g., it may not contain antibiotics and other drugs, slaughter byproducts, plastic pellets for roughage, manure refeeding, or formulas containing urea). In addition, the poultry may not be given growth promoters or hormones, whether implanted, ingested, or injected, including antibiotics and synthetic trace elements used to stimulate growth or production. Poultry may not be housed in cages, must have access to the outdoors, and must be able to scratch and dustbathe. Disease and pest management must also be conducted in accordance with organic standards: the farmer may not use subtherapeutic doses of antibiotics, synthetic internal parasiticides on a routine basis; or administer medication—other than vaccinations—in the absence of illness. The birds’ waste must be managed so as not to pollute the environment or contaminate organic products. Burning the waste is prohibited. The processor must also be certified to label poultry as “Certified Organic.”
NUTRITIONAL LABELING
The USDA’s Food Safety Inspection Service requires single-ingredient retail cuts of poultry to be labeled with nutritional information unless processed under an approved exemption. For more information on nutritional labeling for meat, contact the Wyoming Department of Agriculture.
30 | Poultry
Eggs
Eggs are regulated by both federal and state laws and regulations.
FEDERAL EGG PRODUCTS INSPECTION ACT
The USDA has the authority to regulate eggs and egg products pursuant to the federal Egg Products Inspection Act of 1970. The USDA Agricultural Marketing Service implements the act. The statute and implementing regulations apply to all growers and egg handlers who and facilities that handle or process shell eggs for sale in interstate commerce.
The Agricultural Marketing Service inspects all facilities of egg handlers, including any transport vehicles, to ensure that shell eggs destined for sale to the public are kept under refrigeration at an ambient temperature of no greater than 45°F after packing. An inspection must be conducted at least once each calendar quarter.
Facilities that process shell eggs are subject to continuous inspection when processing eggs for sale in interstate commerce. The processing plant must be maintained in sanitary operating condition at all times. Detailed requirements for the plant and sanitation controls are set forth in the regulations. These include the provision of hot and cold potable water, adequate toilet and hand-washing facilities, protections against dust, dirt, and pests, and proper sewage and waste disposal facilities such as refuse rooms to ensure that waste products and edible eggs are kept separate. They also include requirements for new construction to ensure that a plant’s interior rooms
Poultry | 30

are easy to clean and maintain, and that the building is protected against infestations of pests and rodents. In addition, the plant must have space and equipment necessary for use by the inspector. The regulations also set forth requirements for maintaining the cleanliness of egg washing and drying facilities.
Labeling
All containers of shell eggs must be labeled, and the labels must meet requirements of the USDA Agricultural Marketing Service. The containers must indicate that refrigeration is required (“Keep Refrigerated”). The label must also include the name, address, and ZIP code of the packer or distributor, the net contents of the container, the grade of the product, the official identification and plant number, and the lot number or date of production. The official symbol of inspection is provided in the regulations.
U.S. Food and Drug Administration Egg Safety Rule
The FDA’s Final Rule on egg safety, Guidance for Industry: Prevention of Salmonella enteritidis in Shell Eggs During Production, Storage, and Transportation, requires shell egg producers to implement measures to prevent Salmonella enteritidis from contaminating eggs on the farm and further growth during storage and transportation. The rule applies to producers having more than 3,000 birds. Producers who sell all their eggs directly to consumers or have less than 3,000 hens are not covered by the rule.
The Centers for Disease Control and Prevention developed a page to inform the public about the risks of Salmonella as well as preventive measures one can take to reduce the risks. Consumers and producers can find the information at www.cdc.gov/salmonella.
Organic Eggs
For eggs to be labeled “Organic,” the chicks must be managed as organic beginning from the second day of life. The layers must be fed 100% organic feed, which may not contain animal drugs, antibiotics, or slaughter byproducts. Layers may not be housed in cages, must have access to the outdoors, and must be able to scratch and dustbathe. Disease and pest management must also be conducted in accordance with organic standards. The
birds’ waste must be managed so as not to pollute the environment or contaminate organic products. Burning of the waste is prohibited.
Exemption for Small-Scale Producers
Farmers who sell less than $5,000 in annual egg sales are exempt from the requirements of third-party organic certification, but may still use the term ‘organic’ in their labels provided it is not misbranding or misleading.
WYOMING RULES
Eggs offered for sale in intrastate commerce (within Wyoming) are governed by the Wyoming Food Safety Rule, which is implemented by the Wyoming Department of Agriculture’s Consumer Health Services division.
Eggs that are graded can be sold to inspected establishments to be used in processing. The grader must meet facility requirements and have gone through training, standardization, and certification.
U.S. STANDARDS FOR QUALITY IN
SHELL EGGS
Following is a summary of U.S. standards for quality of individual shell eggs. For more detailed requirements, see the USDA publication United States Standards, Grades, and Weight Classes for Shell Eggs.
AA Quality
For AA quality, the shell must be clean, unbroken, and practically normal. The air cell must not exceed 1/8 inch in depth, may show unlimited movement, and may be free or bubbly. The white must be clear and firm so that the yolk is only slightly defined when the egg is twirled before the candling light. The yolk must be practically free from apparent defects.
A Quality
For A quality, the shell must be clean, unbroken, and practically normal. The air cell must not exceed 3/16 inch in depth, may show unlimited movement, and may be free or bubbly. The white must be clear and at least reasonably firm so that the yolk outline is only fairly well defined when the egg is twirled before the candling light. The yolk must be practically free from apparent defects.
32 | Poultry
Practically Normal (AA or A Quality)
A ‘Practically Normal’ (AA or A quality) egg has a shell that is unbroken, approximates the usual egg shape, and is sound and free from thin spots. Ridges and rough areas that do not materially affect the shape and strength of the shell are permitted.
B Quality
For B quality, the shell must be unbroken, may be abnormal, and may have slightly stained areas. Moderately stained areas are permitted if they do not cover more than 1/32 of the shell surface if localized, or 1/16 of the shell surface if scattered. Eggs having shells with prominent stains or adhering dirt are not permitted. The air cell may be more than 3/16 inch in depth, may show unlimited movement, and may be free or bubbly. The white may be weak and watery so that the yolk outline is plainly visible when the egg is twirled before the candling light. The yolk may appear dark, enlarged, and flattened, and may show clearly visible germ development, but no blood due to such development. It may show other serious defects that do not render the egg inedible. Small blood spots or meat spots (aggregating not more than 1/8 inch in diameter) may be present.
Abnormal (B Quality)
An ‘abnormal’ (B quality) egg has an unbroken shell that is somewhat unusual, decidedly misshapen, faulty in soundness or strength, or shows pronounced ridges or thin spots.
Dirty
A ‘dirty’ egg has an unbroken shell, with adhering dirt or foreign material, prominent stains, or moderate stains covering more than 1/32 of the shell surface if localized or 1/16 of the shell surface if scattered.
Check
A ‘check’ egg has a broken or cracked shell, but its shell membrane is intact and the contents do not leak. A ‘check’ is considered lower in quality than a ‘dirty’.
Poultry | 32
Leaker
A ‘leaker’ has a crack or break in the shell and shell membrane to the extent that the egg content is exuding or free to exude through the shell.
Loss Egg
A ‘loss’ egg is inedible, smashed, or broken, or its contents are leaking, cooked, frozen, or contaminated.
WYOMING WEIGHT CLASSES FOR
CONSUMER GRADES FOR SHELL EGGS
|
Size or Weight Class Minimum |
Net Weight Per Dozen |
|---|---|
|
oz |
|
|
Jumbo |
30 |
|
Extra Large |
27 |
|
Large |
24 |
|
Medium |
21 |
|
Small |
18 |
|
Peewee |
15 |
The Wyoming Food Safety Rule requires that sellers gather eggs promptly (within 24 hours) and keep them refrigerated at an ambient temperature of 45°F or lower. The container in which eggs are marketed for sale must be new and labeled with the number of eggs in the carton, their grade, the name and address of the grower, the packaging date, safe handling instructions, and the wording “Keep Refrigerated.”
In addition, egg growers are expected to maintain a sanitary operation, including an egg room/candling and grading room.
Wyoming’s standards are intended to protect consum
ers from eggs that could harm human health which are injurious or likely to be injurious to health due to the condition of the shell or its contents, or the manner in which eggs are processed, handled, shipped, stored, displayed, sold or offered for sale.
Labeling Claims
Wyoming law does not address the claims that may be made when marketing eggs for sale within the state. For example, the term ‘fresh’ is not defined, nor is ‘organic’ (though the USDA has a federal program for certifying organic). Industry or local custom may informally define terms such as ‘Free Range,’ which one could reasonably expect to be produced from laying chickens that are ‘cage free’ or have access to a suitable outdoors environment. Eggs may be labeled as ‘Fertile’ or ‘Brown’ providing these eggs meet all other applicable requirements.
Ungraded Eggs
Eggs can be sold as ‘ungraded.’ The Wyoming Food Rule already allows sales of ungraded eggs consistent with existing USDA regulations and exemptions. Eggs must be clean and refrigerated. If desired, used cartons that are clean and in good condition may be used. The carton should be labeled with the name and address of the producer, a packaging date, and the words “Ungraded” and “Keep Refrigerated.” Producers of ungraded eggs cannot use cartons that contain the USDA shield, even if it is marked out.

34 | Poultry
Raw Fruits, Vegetables, and Nuts
FEDERAL REQUIREMENTS
Entities and individuals engaged solely in the harvesting, storage, or distribution of raw agricultural commodities, i.e., fresh, unprocessed fruits and vegetables, are exempt from compliance with the Good Manufacturing Practices set forth in federal regulations. It is assumed that such commodities will be adequately cleaned and prepared prior to sale to the public. Sales of raw fruits and vegetables are also exempt from compliance with HACCP.
Fresh, unprocessed fruits and vegetables are exempt from compliance with most mandatory inspection and labeling requirements, however, even though most produce farms in Wyoming will either not be covered by the FSMA Produce Safety Rule because they sell less than $25,000 of produce on average each year or they are qualified exempt, even the qualified exempt farms have labeling and recordkeeping requirements. Winegrapes are covered by the Rule, although they may be exempt if sold for commercial wine production, but even exempt produce has a recordkeeping requirement.
That notwithstanding, the USDA Agricultural Marketing Service has developed a detailed set of practices,
Raw Fruits, Vegetables, and Nuts | 34

requirements, and inspection services to standardize marketing of many types of produce (e.g., apples, grapes, citrus, peanuts, pecans, honey, etc.). Voluntary U.S. grade standards are promulgated pursuant to authority articulated in the Agricultural Marketing Act of 1946. The standards are used to provide a point of reference and comparison, assist with marketing and quality control, and provide a basis for determining loan values for the federal Farm Credit Administration. A grower must comply with these requirements and obtain the necessary inspection certification to make claims about the grade or quality of these products, and the products must be labeled accordingly. Restaurants, grocery stores, and food processors may require inspection and certification pursuant to this program.
To obtain the agency’s inspection and certification services, which are provided on a fee-for-service basis, a grower must file an application for inspection. This is done in an office of inspection at any destination or terminal market, or with any inspector. Each application for inspection service must include the:
The inspector will take samples of the products and test them for quality and safety and comportment with applicable product standards established by the federal or state agency. The inspector will issue a certificate for each lot inspected, and, upon request and payment of fees, will prepare an inspection report for the grower’s use. The grower may appeal the inspection if dissatisfied with the results. Growers must comply with HACCP plan requirements, Good Manufacturing Practices, and other standards if the produce is processed—including freezing—prior to sale. These standards cover everything from packing and storage to color variation and tolerances for pesticide residues. The standards and tolerances are set forth by type of fruit, vegetable, and nut in Title 7 of the Code of Federal Regulations, Subchapter C, Part 51. These regulations are developed and implemented by the USDA Agricultural Marketing Service. The rules also set forth penalties for violations/misbranding. If selling products to a retail store, the producer must supply the information on the invoice or package per Country of Origin Labeling requirements under the Agricultural Marketing Service.
WYOMING RULES
In Wyoming, raw, uncut fruits and vegetables or grains in their natural state may be sold in intrastate commerce without licensing as long as the producer doing the selling. All products are not exempt from inspection. The Wyoming Department of Agriculture does not routinely inspect produce or grain producers, but it does inspect producers if they are requested to by the FDA for contract inspections that are assigned. The Wyoming Department of Agriculture would also inspect and investigate if there were a recall or foodborne outbreak. Sprouts are not exempt from inspection and must comply with the Wyoming Food Safety Rule as well as FDA regulatory requirements. The FDA has published nonbinding guidance for the safe production and processing of fruits and vegetables and to minimize food safety hazards. You can find these by doing an Internet search for “Guide to Minimize Microbial Food Safety Hazards of Fresh-cut Fruits and Vegetables”.
36 | Raw Fruits, Vegetables, and Nuts
Bees and Honey
FEDERAL REQUIREMENTS
Federal regulations regarding the protection of honey bees from pests and pathogens are set forth in the U.S. Code of Federal Regulations (CFR), the compilation of the general and permanent regulations published in the Federal Register. Regulations regarding bees, beekeeping byproducts, and beekeeping equipment are in 7 CFR Part 322. This part does not contain reference to standards or grades of honey. As with other fresh agricultural products, certification of grades for comb and extracted honey is available from the USDA Agricultural Marketing Service on a fee-for-service basis. To learn more about grades of honey, do an Internet search for “United States Standards for Grades of Extracted Honey”.
WYOMING APIARIES
Wyoming regulates the apiary industry via Wyoming’s “Apiary Registration and Inspection” law (Wyoming Statutes, Title 11, Chapter 7). The intent of the law is to help prevent the spread of disease and allow for disease control. The law describes numerous points, including the following:
Bees and Honey | 36

If the department determines that too many hobbyist apiaries, for instance, are being registered within too close proximity of each other or other established apiaries, then there may be a danger of the spread of bee diseases, parasites, or pests among bees or apiaries, or that the proper feeding and honey flow of established apiaries may be affected. So the department may refuse to grant any further registration in that locality.
A beekeeper can request an apiary inspector from the department when new bees have been imported or if a hive health problem is suspected.
HONEY PROCESSING
If a beekeeper wishes to process honey in a honey room, then the regulatory authority would shift to the Wyoming Food Safety Rule, and the processing location and equipment would be subject to inspection if the beekeeper wished to sell beyond was is allowed by the Wyoming Food Freedom Act.

38 | Bees and Honey

Wildcrafting
Wildcrafting – or foraging – is gathering herbs, plants, and fungi which are uncultivated, customarily for food or medicinal purposes. Often fruit, berries, mushrooms and other plant materials are collected from yards, gardens, lots, parks and wildlands such as prairies and forests, which are either privately or publicly owned. A couple of issues are notable for wildcrafting:
1.Was the product collected legally?
2.Can the collected item be sold as food?
FEDERAL REQUIREMENTS
The rules for gathering plant materials on federal lands may vary according to the manager: national forests are
managed by the Forest Service (which is part of the Department of Agriculture), and national parks, wildlife refuges and other lands are managed by the National Park Service, the Fish and Wildlife Service and the Bureau of Land Management, respectively (which are part of the Department of the Interior). The regional office of each would be the responsible authority.
For national forests, in general, harvesting “incidental amounts” of mushrooms and berries for personal use may be allowed without a permit. This is often considered to be one gallon of berries or mushrooms. Permits for more significant amounts would require a permit. Mushrooms are a popular item, and can be gathered

Wildcrafting | 38
under incidental harvest for personal use only. Selling or exchanging mushrooms gathered incidentally is a violation of Federal Regulations (Title 36 CFR 261.6(f), punishable by a fine of not more than $5,000 or imprisonment for not more than six months, or both. Harvesting from wilderness areas is prohibited.
For national parks, the Code of Federal Regulations indicates that possessing, destroying, removing, digging up, or disturbing “plants or the parts or products thereof.” (36 C.F.R. § 2.1) is prohibited. However, the park superintendent may create an exception from the ban and allow foraging. The superintendent would then set controls for the type, method, use, quantity, and location of the foraging.
The US Food and Drug Administration has stringent regulations regarding the marketing and sale of medicines. Language on advertising that can be construed as diagnosing, preventing, treating, or curing disease may violate FDA and Federal Trade Commission regulations regarding product claims about an unapproved drug, which herbal remedies would be considered to be.
WYOMING RULES
In Wyoming, state land management includes state forests and parks. Harvesting a small number of wild plants, mushrooms, berries, and other plant materials for personal, non-commercial use is generally allowed on all Wyoming state lands (which include State Trust Lands managed by the Office of State Lands and Investments, the office of State Parks and Cultural Resources, and the Wyoming Game and Fish Department. Use beyond personal might warrant a temporary use permit on State Trust Lands. Remember that activities on State Trust Land, as on other lands, are at your own risk.
Local entities such as cities and county own and manage property such as parks and may have rules regarding access and use.
Wyoming state law addresses wild mushrooms specifically. The Wyoming Food Safety Rule, in Chapter 3, contains this clause:
Section 3. Wild Mushrooms.
(a) Except as specified in Chapter 3, Section 3(b), mushroom species picked in the wild shall be obtained from sources where each mushroom is individually inspected and found to be safe by an approved mushroom identification expert.
The Wyoming Food Freedom Act allows the sale of foraged food such as wild mushrooms to the end consumer, and the seller must inform him or her that the product is not licensed and inspected. As with other Food Freedom products, any foraged item may not be sold to a food establishment (a place with an inspected kitchen, such as a restaurant or institution) since the source is not an approved one, and the product may not be sold across state lines.

40 | Wildcrafting

Agritourism
Agritourism is the practice of diversifying a farm or food production business to allow members of the general public to visit the property for purposes of learning about operations, taking part in activities centering on the farm or ranch theme for entertainment and/or education, holding an event, engaging in harvesting produce for personal consumption (e.g., U-pick), or purchasing farm products (e.g., Christmas trees, farm dinners).
Agritourism activities can create risks both to the customer as well as the operator, so before starting such ventures operators should check with their insurance provider about any necessary insurance they should purchase to protect themselves and others. Agritourism activities may already be covered under an umbrella policy, but there may need to be the addition of a rider, depending on the activity. Have a discussion with your insurance provider prior to inviting the public onto your farm or ranch.
FARM STORES AND ROADSIDE MARKETS
City and county governments regulate local land uses, including agricultural production and food-related businesses. It is essential to contact the planning and zoning office in the county in which the farm store or roadside market is located for site-specific guidance.

Agritourism | 40

Alcohol
Alcohol production and marketing fairly heavily regulated in the US, so making and selling beer, wine, ciders and distilled products can be complicated at the federal, state, and local levels.
The U.S. Department of Treasury’s Alcohol and Tobacco Tax and Trade Bureau (TTB) regulates the manufacturing and distribution. In Wyoming, the Department of Revenue regulates the manufacturing, distribution, and retail tiers. The Wyoming Department of Agriculture regulates food-manufacturing facilities. And local government regulates the retail tier, and through zoning regulations may have requirements about the location of a brewery, brewpub, or distributor.
FEDERAL REQUIREMENTS
The U.S. Alcohol and Tobacco Tax and Trade Bureau (TTB) enforces the Federal Alcohol Administration Act (FAA Act) and sets the rules for the production, distribution, labeling, advertising, trade and pricing practices, credit, container characteristics, and alcoholic content of each alcoholic beverage.
The TTB is the first of a three-tier system of statutes which requires licensed alcoholic beverage producers be separate from licensed alcoholic beverage distributors, which are separate from retailers. So, manufacturers cannot distribute or sell at retail; distributors cannot manufacture or sell at retail; and retailers cannot manu

42 | Resources
As at the federal level, a state manufacturer’s license is required, but the appropriate federal permits and licenses must first be approved. Wyoming permits are available for manufacturing wine, distilled alcohol, and beer. It is illegal to own a still or to manufacture alcoholic beverages without a license. However, it is acceptable to brew, and a Wyoming microbrewery is defined as producing less than 50,000 barrels per year and no less than 50 barrels per year. Although the labeling is approved at the federal level, the Wyoming Department of Agriculture may review a micro beer to assure it is labeled properly. Naturally, these operations must adhere to federal and state construction standards as well as zoning restrictions set by local (city and county) governments. It may be to a microbrewery or distillery’s advantage to add a food preparation area to their facility, which, although it would become another area to maintain an inspection for, food is typically expected as an option when providing drinks.
The Wyoming Liquor Division is the exclusive wholesale distributor and seller of alcoholic liquor for resale, except beer, so products produced for wholesale will pass through a warehouse in Cheyenne for redistribution, save for those sold onsite.
Home-brewed beer, wine and spirits produced for personal consumption are excise-free. But alcohol ventures such as microbreweries will need to pay an excise on any product produced to sell. Wyoming law sets the rates at:
•three-fourths of one cent ($.0075) per one hundred (100) milliliters (3.4 ounces) on wine;
•two and one-half cents ($.025) per one hundred (100) milliliters (3.4 ounces) on spirits; and
•one-half cent ($.005) per liter (33.8 ounces) on malt beverages (beer).
The Wyoming Food Freedom Act does not apply to beer, wine or distilled products, so alcoholic beverages made at home cannot be sold to the end consumer as a Food Freedom product.
Wyoming Department of Revenue, Liquor Division, eliquor.wyoming.gov
facture or distribute. The structure was intended to end the practice of producer-owned retailers, which were considered anti-competitive. Some well-known exceptions include taprooms (which have both manufacturing and retail) and brewpubs (also manufacturing and retail, and sometimes distribution, too).
Before beginning an alcohol venture, the business must apply for and receive approval from the TTB. The application will focus on:
•Operating permits, label approvals, formula approvals;
•Distribution; and
•Taxes.
The TTB will be interested the venture’s final plans for what it wants to produce (including recipes), how it wants to produce it (equipment and facilities), and how it will market and label it (claims that will be made to the public). And each owner of more than a 10% stake in the company must have a background check.
As to taxes, there are separate federal tax rates for each different alcoholic beverage categories. The rates collected for some common craft categories are:
•$3.50 per barrel of beer for the first 60,000 barrels for small brewers. (A barrel is about 31.5 US gallons).
•$0.07 per gallon of wine (under 16% alcohol by volume) for the first 30,000 gallons.
•$2.70 per gallon of distilled spirits for the first 100,000 gallons.
The state of Wyoming collects further taxes.
Department of the Treasury, Alcohol and Tobacco Tax and Trade Bureau, www.ttb.gov.
WYOMING RULES
Each state has the authority to regulate the production, sale, and distribution of alcohol within its borders, and Wyoming regulates alcoholic beverages under Title 12 (Alcoholic Beverages) of the Wyoming Statutes. The law is administered by the Liquor Division of the Wyoming Department of Revenue.
Resources | 42


Resources
WYOMING AGENCIES AND GROUPS
Wyoming Department of Agriculture, Consumer Health Services Division oversees the safety of the state’s food supply. Consumer Health Services is also responsible for environmental health duties including swimming pool inspection, assisting with drinking water safety, assisting communities with nuisance complaints, etc. wyagric.state.wy.us/divisions/chs
Wyoming Department of Agriculture assists the citizens of Wyoming to live safe and healthy lives, promote and preserve the agricultural community, be responsible stewards of natural resources, and achieve integrity in the marketplace. It offers a variety of programs, including food safety workshops and technical services workshops including pesticide applicator training.
wyagric.state.wy.us
Wyoming Food Safety Coalition educates the public as to food safety practices, and it aims to reduce the risk of foodborne illness. wyomingfoodsafety.org
Wyoming Department of Revenue administers and collects mineral and excise taxes, oversees the valuation of property and wholesale distribution of alcohol beverages, and enforces liquor control laws. revenue.wyo.gov
Wyoming Department of Workforce Services administers training programs, unemployment insurance benefits, and job-seeking services for those who are unemployed and those who are currently working.
www.wyomingworkforce.org. The Workforce Development Training Fund is at
wyomingworkforce.org/businesses/wdtf
Wyoming Department of Revenue, Liquor Division enforces regulations for the production, sale, and distribution of alcohol within Wyoming and is the exclusive wholesale distributor and seller of alcoholic liquor for resale, except beer. eliquor.wyoming.gov
Wyoming Farmers Marketing Association works to promote farmers’ markets across Wyoming, where “finding fresh, locally grown produce is a luxury.”
www.wyomingfarmersmarkets.org
Wyoming Business Council functions as the economic development agency of the State of Wyoming. It helps entrepreneurs develop business plans, identify problems, find capital, brainstorm strategies, and propel their businesses to a profitable future. www.wyomingbusiness.org
Wyoming Business Council’s Agriculture and Food Products offers a variety of programs focused on reaching new markets and adding value to products.
wyomingbusiness.org/ag-food
Wyoming Business Council’s Grown in Wyoming program promotes agricultural products from Wyoming. Members can use a logo and promotional materials and get market exposure through consulting, promotion and brand campaigns in addition to being featured in profiles and stories on the website, on social media and in materials directed toward grocery stores, restaurants and consumers. www.growninwyoming.org
Wyoming Business Council’s Made In Wyoming program assists Wyoming businesses in accessing new markets, as well as growing through brand awareness, selling opportunities, and trade show assistance.
madeinwyoming.org
Wyoming Main Street is a program of the Wyoming Business Council that offers support for Main Street communities throughout Wyoming and businesses located in Main Street communities.
www.wyomingbusiness.org/mainstreet
Wyoming Secretary of State’s Office is the place to register a business entity. soswy.state.wy.us
Wyoming State Bar regulates the practice of law in Wyoming. Lawyers can be found on its website.
www.wyomingbar.org
Wyoming State Chamber of Commerce assists businesses and enhances economic growth through advocacy, education, and communication.
www.wyomingchambers.com
Wyoming Trademark database catalogs Wyoming state trademarks issued since 1906. New applications and renewals are added monthly, and there are many inactive applications and mark images for Wyoming trademarks. trademarks.wyo.gov
Wyoming Women’s Business Center offers current and prospective women business owners in Wyoming
Resources | 44
the business assistance they need, including access to business counseling, capital, microloans, and training, technical assistance, and networking opportunities.
www.wyomingwomen.org
Wyoming Farm to School Resource Guide connects Wyoming schools, producers, and other interested participants with resources for building successful farm to school programs.
edu.wyoming.gov/downloads/nutrition/farm-to-school-resource-guide-final.pdf
UNIVERSITY OF WYOMING COLLEGE OF AGRICULTURE AND NATURAL RESOURCES
Academic Departments, County Extension Offices, and Research & Extension Stations
College of Agriculture and Natural Resources
www.uwyo.edu/uwag
Department of Agricultural and Applied Economics www.uwyo.edu/agecon
Department of Animal Science www.uwyo.edu/anisci
Department of Ecosystem Science and Management www.uwyo.edu/esm
Department of Family and Consumer Sciences
www.uwyo.edu/fcs
Department of Molecular Biology
www.uwyo.edu/molecbio
Department of Plant Sciences
www.uwyo.edu/plantsciences
Department of Veterinary Sciences www.uwyo.edu/vetsci
Program in Agricultural Communications
www.uwyo.edu/agprograms/departments/ag-communications.html
Program in Microbiology
www.uwyo.edu/uwag/college-overview/departments/microbiology.html
Wyoming Agricultural Experiment Station (with Research and Extension centers in Laramie, Lingle, Powell,
and Sheridan) www.uwyo.edu/uwexpstn
America’s Extension Service is a nationwide partnership of national, state, and county governments in which a state’s land-grant university offers resources to address public needs through a network of county offices supported by specialists at the university. Its aim is to strengthen the social, economic, and environmental well-being of families, communities, and agricultural enterprises. nifa.usda.gov/extension
University of Wyoming Extension State Office – (307) 766-5124 www.uwyo.edu/uwe
Albany County – (307) 721-2571
wyoextension.org/albanycounty
Big Horn County – (307) 765-2868
www.wyoextension.org/bighorncounty
Campbell County – (307) 682-7281
wyoextension.org/campbellcounty
Carbon County – (307) 328-2642
wyoextension.org/carboncounty
Converse County – (307) 358-2417
www.wyoextension.org/conversecounty
Crook County – (307) 283-1192
wyoextension.org/crookcounty
Fremont County/Lander Office – (307) 332-2363
www.wyoextension.org/fremontcounty
Fremont County/Riverton Office – (307) 857-3654 www.wyoextension.org/fremontcounty
Goshen County – (307) 532-2436
wyoextension.org/goshencounty
Hot Springs County – (307) 864-3421
wyoextension.org/hotspringscounty
Johnson County – (307) 684-7522
wyoextension.org/johnsoncounty
Laramie County – (307) 633-4383
www.wyoextension.org/laramiecounty
Lincoln County/Afton Office – (307) 885-3132
46 | Resources
www.uwyo.edu/uwe/county/lincoln
Lincoln County/Kemmerer Office – (307) 828-4091 www.uwyo.edu/uwe/county/lincoln
Natrona County – (307) 235-9400
wyoextension.org/natronacounty
Niobrara County – (307) 334-3534
www.wyoextension.org/niobraracounty
Park County – Cody Office - (307) 527-8560
www.wyoextension.org/parkcounty
Park County/Powell Office – (307) 754-8836
www.wyoextension.org/parkcounty
Platte County – (307) 322-3667
wyoextension.org/plattecounty
Sheridan County – (307) 674-2980
www.wyoextension.org/sheridancounty
Sublette County – (307) 367-4380
www.uwyo.edu/uwe/county/sublette
Sweetwater County – (307) 352-6775
www.uwyo.edu/uwe/county/sweetwater
Teton County – (307) 733-3087
www.wyoextension.org/tetoncounty
Uinta County – (307) 783-0570
www.uwyo.edu/uwe/county/uinta
Washakie County – (307) 347-3431
www.uwyoextension.org/washakiecounty
Weston County – (307) 746-3531
www.wyoextension.org/westoncounty
Wind River Indian Reservation – (307) 332-2135
www.uwyo.edu/uwe/county/wind_river
Resources | 46

Casper Office
Serving Converse, Natrona, Niobrara & Platte counties
(307) 234-6685
300 South Wolcott, Suite 300
Casper, WY 82601
Cheyenne Office
Serving Goshen & Laramie counties
(307) 772-7371
LCCC Career & Technical Building, 2nd Floor
1400 East College Drive
Cheyenne, WY 82007
Gillette Office
Serving Campbell, Crook, Johnson, Sheridan & Weston counties
(307) 682-5232
2001 West Lakeway Road, Suite D
Gillette, WY 82718
Jackson Office
Serving Fremont and Teton counties
(307) 851-2029
215 West Gill Ave.
Jackson, WY 83001
Laramie Office
Serving Albany & Carbon counties
(307) 766-3505
406 S. 21st
Laramie, WY 82071
Powell Office
Serving Big Horn, Hot Springs, Park & Washakie counties
(307) 754-2139
111 South Day St.
Powell, WY 82435
Riverton Office
Serving Fremont and Teton counties
(307) 851-2029
213 West Main Street, Suite C
Riverton, WY 82501
Rock Springs Office
Serving Lincoln, Sublette, Sweetwater & Uinta counties
(307) 352-6894
1400 Dewar Drive #208
Rock Springs, WY 82901
State Office
Serving the state of Wyoming
(800) 348-5194
406 S. 21st
Laramie, WY 82071
WYOMING SMALL BUSINESS DEVELOPMENT CENTER NETWORK
America’s SBDC is a nationwide network of Small Business Development Centers (SBDCs), providing assistance to small businesses and aspiring entrepreneurs throughout the United States and its territories. The Wyoming Small Business Development Center Network consists of multiple offices throughout the state with business consultants who provide basic business education through consulting, classes and webinars, publica
tions, web services, and referrals to related agencies. It is a partnership between the University of Wyoming, Wyoming Business Council, and U.S. Small Business Administration. www.uwyo.edu/sbdc
The SBDC also includes the Wyoming Market Research Center, which offers free market research reports. The Wyoming Procurement Technical Assistance Center assists business owners who desire to sell products and/or services to the government.
48 | Resources
GRANTS AND LOANS
Wyoming Farm to School Program
The Wyoming Department of Education’s child nutrition programs works with schools, producers, and others to improve access to local foods in eligible schools through the department’s Farm to School program.
edu.wyoming.gov/beyond-the-classroom/nutrition/farm-to-school
Wyoming Small Business Energy Audit/Retrofit Program
The Wyoming Small Business Energy Audit/Retrofit Program funds 75% of the cost of an energy audit and some energy efficiency improvements. When funding is available, the program can also pay a fraction of the actual improvements identified in the audit, such as lighting upgrades and insulation. The cost of the audit and associated improvements cannot exceed $5,000. Residences and housing units are not eligible.
www.wyomingbusiness.org/content/business-energy-audits-retrofits
Wyoming Business Council Value-Added
Agriculture Loan Program
Wyoming producers, producer groups and agribusiness entities may work with their lender to apply for the Value-Added Agriculture Loan program. The bank is the applicant and the producer, producer group or agribusiness entity is the beneficiary.
Resources | 48
www.wyomingbusiness.org/content/businesses-seeking-financing
Wyoming Trade Show Incentive Grant Program
The Wyoming Business Council Trade Show Incentive Grant program helps defray costs for Wyoming businesses attending trade shows with the intention of expanding into regional, national or international markets. Wyoming businesses are eligible to apply for Trade Show Incentive Grant funds if they meet the following criteria:
1. Private-sector, Wyoming-based company wishes to expand into new markets.
2. Can demonstrate ability to capitalize on the trade show or has attended a trade show training program.
3. Can document the event is an appropriate venue for the company.
This is a matching program.
Companies may receive a maximum of three (3) grants during the WBC fiscal year, (July 1-June 30).
There is a maximum per application award of $2,500. The total grant award is limited to 50% of the actual eligible expenditures. The minimum reimbursable amount is $1,000. The maximum a company can receive is $7,500 over the life of the program and no more than $2,500 in a year.
50 | Resources

Wyoming Business Council STEP Foreign Market Trade Event Grant
The Wyoming Business Council (WBC) offers State Trade Expansion Program (STEP) Trade Incentive Grants that are funded in part through a grant with the U.S. Small Business Administration to eligible small businesses based in Wyoming. The aim is to increase the number of Wyoming small businesses exporting to foreign markets and to boost the value of exported goods and services. Reimbursable awards are for 75% of eligible expenses not to exceed $4,000. The maximum number of awards per grant period is two. During the
trade event, grant recipients are required to hold business-to-business meetings with potential clients.
Eligible expenses for reimbursement include: airfare; business-to-business meetings coordinated by qualifying providers; market analysis by qualifying providers; related services offered by the U.S. Commercial Service and World Trade Center Denver; interpretation service; website and marketing material translation; trade mission participation fee; participation in international trade training workshops; qualifying expenses related to exhibiting at international trade shows; ground transportation costs within the hosting locale; and qualifying hotel and lodging expenses. www.wyomingbusiness.org/exports
Resources | 50
Wyoming Historic Architecture Assistance Fund
The Historic Architecture Assistance Fund through the Wyoming Main Street program will provide the services of architects and structural engineers to the owners of historic buildings or buildings located in Main Street communities to address issues involved with the rehabilitation and use of such properties. The fund cannot support complete architectural or engineering services needed for a complete rehabilitation project. Typical projects that can be funded include a building assessment, structural analysis, analysis of building code and Americans with Disabilities Act requirements, and facade and signage schematic design. This fund is meant to support private property owners who are not eligible for many grant programs. Not-for-profit property owners may also submit applications. wyomingbusiness.org/mainstreet
Wyoming Partnership Challenge Loan
The Wyoming Business Council can participate with a local lender on a loan to a building owner for building improvements to maintain the structure’s historical character. The state’s portion of the participation may be up to 75% of the loan (maximum of $100,000) in a shared note and collateral position with the local lender. www.wyomingbusiness.org/content/businesses-seeking-financing
Wyoming Workforce Development Training Fund
The Wyoming Workforce Development Training Fund is a program that helps employers provide training in their organizations. This fund has three types of grants that address workforce training needs: Business Training, Pre-Hiring Economic Development, and Pre-Obligation. www.wyomingworkforce.org/businesses/wdtf
Wyoming Specialty Crop Grant Program
The Wyoming Department of Agriculture accepts applications for the Wyoming Specialty Crop Grant Program. The department often receives up to $300,000 from the USDA Specialty Crop Block Grant Program contingent upon funding availability. The allocation is to be used solely to enhance the competitiveness of specialty crops in Wyoming by increasing the production and consumption of fruits, vegetables, tree nuts, horti
culture, and floriculture. Competitive grant awards will be considered up to a maximum of $24,500 for specialty crop projects lasting one to two years. In addition, the program will consider awards of up to $50,000 for projects lasting up to three years providing the applicants can justify larger impacts and the need for additional funding. The deadline for applications is typically in March. wyagric.state.wy.us/component/content/article/34-agnews/178-specialty-crop-grant-information
Wyoming Specialty Crop On Farm Research Grants up to $5,000 will be awarded to producers to promote specialty crop on-farm research projects. Wyoming agricultural organizations are eligible to apply for a grant if they meet the following criteria:
1. Be a registered producer in the state of Wyoming.
2. Demonstrate that the agri-business is capable of promoting the use of specialty crop production through approved research project.
3. Have on their team a researcher from a Wyoming college, the University of Wyoming or other Wyoming research expert approved by the Wyoming Department of Agriculture. Eligible expenditures are limited to supplies necessary to complete research. A 25% match is required.
Wyoming Office of State Lands and Investments Farm Loan
Wyoming’s Office of State Lands and Investments operates a farm loan program through which they can make loans to:
52 | Resources
The program is open to eligible Wyoming voters or entities with majority ownership by Wyoming voters. There is a $100 application fee and a 1% origination fee. Loans can be for up to 30 years. lands.wyo.gov/grantsloans/loans/farm
Walmart Community Grant Program
The Walmart Community Foundation is accepting applications for its Community Grant Program. The Foundation awards grants to nonprofits and agencies involved in community and economic development, public safety, and environmental sustainability.
Who is eligible to apply: 501(c)(3) or (19) organizations recognized by the IRS, recognized government entities, K-12 (public, private or charter) schools, community/junior college, state/private college or university, or church or faith-based organizations with proposals that benefit the community at large.
Funding Available: Awarded grands range from $250 to $5,000.
Application Deadline: Applications may be submitted at any time during the funding cycle (February 1 to December 31).
For full application requirements and more information, click here.
FSA Farm Storage Facility Loan Program
The USDA Farm Service Agency (FSA) Farm Storage Facility Loan program provides low-interest financing to producers to build or upgrade storage facilities and to purchase portable (new or used) structures, equipment and storage and handling trucks. The loans are designed to assist a diverse range of farming operations, including small and mid-sized businesses, new farmers, operations supplying local food and farmers markets, non-traditional farm products, and underserved populations.
Loans up to $50,000 can be secured by a promissory note/security agreement, and loans between $50,000 and $100,000 may require additional security. Loans exceeding $100,000 require additional security.
Producers do not need to demonstrate the lack of commercial credit availability to apply. Please see the extensive list of eligible commodities on this factsheet.
For more information, click here.
To contact your local FSA county office, find your local office here.
USDA Funding for Underserved Groups and
Beginning Farmers
The USDA Farm Service Agency (FSA) offers targeted farm ownership and farm operating loans to assist underserved applicants as well as small, beginning, niche and non-traditional farmers and ranchers. This direct and guaranteed loan program offers two types of loans: 1) farm ownership loans, and 2) farm operating loans. Through the direct loan program, FSA also offers Microloans for ownership and operating finance needs focusing on small, beginner farmer, niche and non-traditional farm operations.
To qualify as a beginning producer, the individual or entity must meet the eligibility requirements outlined for direct or guaranteed loans. This includes the fact that the individuals and all entity members must have operated a farm for less than 10 years.
For more information, click here.
USDA Farm Service Agency
The USDA’s Farm Service Agency offers numerous direct and guaranteed loan programs, and can help with the cost of transitioning to organic, organic certification, real estate, buildings, repairs, insurance, field buffers, routine operating expenses, storage and handling equipment, crop losses, soil and water conservation, mapping field boundaries, and acreage reporting.
Direct Farm Ownership Loans are used to purchase or enlarge a farm or ranch, construct a new or improve existing farm or ranch buildings, and for soil and water conservation and protection purposes.
Direct Operating Loans are used to purchase items such as livestock and feed; farm equipment; fuel, farm chemicals, insurance, and family living expenses; make minor improvements or repairs to buildings and fencing; and general farm operating expenses.
Resources | 52

Microloans are operating loans designed to meet the needs of small and beginning farmers, non-traditional, specialty crop and niche type operations by easing some requirements and offering less paperwork. The focus of Microloans is on the financing needs of small, beginning farmer, niche and non-traditional farm operations, such as truck farms, farms participating in direct marketing and sales such as farmers’ markets, CSAs (community supported agriculture), restaurants and grocery stores, or those using hydroponic, aquaponic, organic and vertical growing methods. Eligible applicants may obtain a microloan for up to $50,000. The repayment term may vary and will not exceed seven years. Annual operating loans are repaid within 12 months or when the agricultural commodities produced are sold. Interest rates are based on the regular operating loan rates that are in effect at the time of the microloan approval or microloan closing, whichever is less.
Direct Farm Ownership Loans are used to purchase or enlarge a farm or ranch, construct a new or improve existing farm or ranch buildings, and for soil and water conservation and protection purposes.
Loan Guarantees enable lenders to extend credit to family farm operators and owners who do not qualify for standard commercial loans. Farmers receive credit at reasonable terms to finance their current operations or to expand their business; financial institutions receive additional loan business and servicing fees, as well as other benefits from the program, such as protection from loss.
Beginning Farmers and Ranchers loans provide credit opportunities to eligible family farm and ranch operators and owners who have been in business less than 10 years.
Emergency Loans help farmers and ranchers recover from production and physical losses due to drought,
flooding, other natural disasters or quarantine.
www.fsa.usda.gov/programs-and-services/farm-loan-programs
USDA Organic Certification Cost Share Program
Certified organic producers and handlers can apply at the Wyoming Department of Agriculture or one of USDA’s FSA local county offices to receive a reimbursement for up to 75% of certification costs each year up to $3000 with $750 per certification scope (crops, livestock, wild crops, handling or state program fees). Organic certification is required. Transitional certification fees are not eligible. www.ams.usda.gov/services/grants/occsp
USDA Natural Resource Conservation Service
The Environmental Quality Incentives Program (EQIP) is a voluntary conservation program that helps agricultural producers promote agricultural production and environmental quality. Through EQIP, agricultural producers receive financial and technical assistance to implement structural and management conservation practices that optimize environmental benefits on working agricultural land. EQIP is open to all eligible agricultural producers and submitted applications may be considered or evaluated in multiple funding pool opportunities. Applicants must be agricultural producers and owners of non-industrial private forestland and Tribes are eligible to apply for EQIP. Eligible land includes cropland, rangeland, pastureland, non-industrial private forestland and other farm or ranch lands. Applicants must control or own eligible land; comply with adjusted gross income limitation (AGI) provisions; be in compliance with the highly erodible land and wetland conservation requirements; and develop an NRCS EQIP plan of operations. To apply for EQIP, contact a Wyoming service center. offices.sc.egov.usda.gov/locator/app
The EQIP Organic Initiative provides financial and technical assistance to implement conservation practices, or activities like conservation planning, that address natural resource concerns, especially related to the transition to organic production. Payments are made to participants after conservation practices and activities identified in an EQIP plan of operations are implemented. Contracts can be up to $20,000 annually, and/or up to $80,000 over a six-year contract.
The EQIP Seasonal High Tunnel Initiative provides cost-share funding and technical assistance to farmers who want to extend the growing season on their farms by using high tunnels. These funds can be used to assist participants in constructing high tunnel systems, planting windbreaks and shelterbelts or renovating existing windbreaks.
The Agricultural Management Assistance (AMA) provides financial and technical assistance to agricultural producers to voluntarily address issues such as water management, water quality, and erosion control by incorporating conservation into their farming operations. Producers may construct or improve water management structures or irrigation structures; plant trees for windbreaks or to improve water quality; and mitigate risk through production diversification or resource conservation practices, including soil erosion control, integrated pest management, or transition to organic farming. The program pays financial assistance of up to 75 percent of the cost of installing conservation practices. The total AMA payments shall not exceed $50,000 per participant for any fiscal year. Participants are not subject to Highly Erodible Land and Wetland Conservation provisions of the Food Security Act of 1985; however participants are subject to Adjusted Gross Income provisions of the Food Security Act of 1985. Program offers an additional higher cost-share for historically underserved producers. Eligible producers must
54 | Resources
USDA Rural Business Development Grants
The USDA Rural Development’s Rural Business Development Grants is a competitive grants program designed to support targeted technical assistance, training, and other activities leading to the development or expansion of small and emerging private businesses in rural areas that have fewer than 50 employees and less than $1 million in gross revenues. Programmatic activities are separated into enterprise or opportunity-type grant activities. Enterprise projects may include:
Opportunity grants can be used for:
Resources | 54
USDA Value-Added Producer Grants
The USDA Rural Development’s Value-Added Producer Grant program helps agricultural producers enter into value-added activities related to the processing and/or marketing of new products. Value-Added Grant Program funds can be used for working capital, feasibility studies, business plans, and marketing efforts to establish viable value-added businesses. Planning Grants can be for up to $75,000, and Working Capital Grants can be for up to $250,000. In the past, the USDA Rural Development program has issued $18 million in competitive grants in Wyoming. Enactment of a continuing resolution or an appropriations act may affect the availability or level of funding for this program. Applications are typically due in January. www.rd.usda.gov/wy
USDA Rural Energy for America Program (REAP)
The USDA Rural Development’s Rural Energy for America Program provides guaranteed loan financing and grant funding to agricultural producers and rural small businesses for renewable energy systems or to make energy-efficiency improvements. Funds may also be used for the purchase, installation and construction of energy efficiency improvements, such as:
USDA Rural Development Business and Industry Loan Guarantees
Administered by the USDA, this program guarantees loans by eligible local lenders to businesses. Its primary purpose is to create and maintain employment and
improve the economic and environmental climate in rural areas. The program typically guarantees losses up to 80% of the original loan amount to the local lender. The inability to obtain other funding by the borrower is not a requirement. www.rd.usda.gov/wy
USDA Farmers Market Promotion Program
The USDA Farmers Market Promotion Program (FMPP) offers two distinct types of grants: (1) Capacity Building; and (2) Community Development, Training, and Technical Assistance Projects. For Capacity Building projects, the minimum award is $50,000 while the maximum is $250,000. For Community Development, Training, and Technical Assistance projects, the minimum grant award is $250,000 while the maximum is $500,000. There are no matching requirements. The grant period is three years. www.ams.usda.gov/services/grants/fmpp
USDA Local Food Promotion Program
The USDA Local Food Promotion Program (LFPP) offers Planning Grants ($25,000 minimum; $100,000 maximum) and Implementation Grants ($100,000 minimum; $500,000 maximum). Unlike the Farmers Market Promotion Program, the Local Food Promotion Program does require a 25% cash or in-kind match. Planning Grants are for up to 18 months. Implementation Grants can be awarded for up to three years. www.ams.usda.gov/services/grants/lfpp
Western SARE Farmer/Rancher Grants
Grants through Western SARE (Sustainable Agriculture Research and Education) support projects conducted by agricultural producers with guidance from a technical adviser. Producers typically use these grants to conduct on-site experiments that can improve their operations and the environment and can be shared with other producers. Grant recipients may also focus on marketing and organic production. A call for proposals is usually released in September, and proposals are due in December.
Farmer/Rancher Grants These one- to three-year grants are conducted by agricultural producers with support and guidance from a technical advisor. Individual farmers or ranchers may apply for up to $20,000, and a group of three or more producers may apply for up to
$25,000. Producers typically use their grants to conduct on-site experiments that can improve their operations and the environment and can be shared with other producers. Grant recipients may also focus on marketing and organic production.
Professional + Producer Grants These one- to three-year grants are similar in concept to the Farmer/Rancher Grants with a few key differences. Instead of a producer serving as the project coordinator, an agricultural professional coordinates the project. A farmer or rancher serves as the project advisor. Applicants can seek up to $50,000 and must have at least five producers involved.
www.westernsare.org/Grants/Types-of-Grants
Organic Farming Research Foundation Research Grants
The Organic Farming Research Foundation accepts proposals for research projects on organic farming and food systems. The foundation encourages farmers, ranchers, graduate students, early career researchers, veterans, and Extension personnel to apply. Priority areas are soil health, innovative weed control, management of emerging insect and disease issues, and livestock health. The deadline for proposals is usually at the end of the year. ofrf.org
Western US Ag Trade Association FundMatch Program
FundMatch is a 50% reimbursement program for eligible international marketing expenses. Participants will conduct activities throughout a program year and complete claims for each activity. Companies can request funds ranging from $2,500 to $300,000 through a yearly application process, based on exporting experience. The minimum funding request is $2,500, which means that the business must spend $5,000 in promotional activities to be reimbursed $2,500 (50%) by WUSATA. Eligible FundMatch expenses cover a flexible and wide range of export marketing activities. The program is only available to value-added ag companies in Western Region considered small business by SBA. Other WUSATA programs include Global Connect (to help make connections) and Export Education (to learn about exporting). www.wusata.org
56 | Resources
Small Business Innovation Grants
The Wyoming SBIR/STTR Initiative (WSSI), a part of the Wyoming SBDC Network, assists all qualified Wyoming small businesses and individuals in accessing the funding opportunities provided by the Small Business Innovative Research (SBIR) and Small Business Technology Transfer (STTR) Programs. The aim is to encourage domestic small businesses to engage in high-growth research and development that has the potential for commercialization and could lead to significant public benefit.
Small Business Innovation Research Phase 0 The Wyoming SBIR program’s Phase 0/00 is a $5,000 contract that can be used to attend SBIR conferences and workshops, communication with and travel to targeted federal agencies, consultant and mentor services for preparation of the Phase I/II proposal, proposal preparation and review, communications with potential customers, analyses to support test data preparation, acquisition of test data for inclusion in the Phase I/II proposal and other activities related to the Phase I/II proposal preparation.
Phase 0 applications are reviewed monthly.
Phase I: Feasibility and Proof of Concept The objective of Phase I is to establish the technical merit, feasibility, and commercial potential of the proposed R/R&D efforts and to determine the quality of performance of the small business awardee organization prior to providing further federal support in Phase II. Phase I awards normally do not exceed $150,000 total costs for 6 months (SBIR) or 1 year (STTR).
Phase II: Research/Research and Development The objective of Phase II is to continue the R/R&D efforts initiated in Phase I. Funding is based on the results achieved in Phase I and the scientific and technical merit and commercial potential of the project proposed in Phase II. Only Phase I awardees are eligible for a Phase II award. SBIR/STTR Phase II awards normally do not exceed $1,000,000 total costs for 2 years.
Phase III: Commercialization The objective of Phase III, where appropriate, is for the small business to pursue commercialization objectives resulting from the Phase I/II R/R&D activities. The NIH SBIR/STTR programs do not fund Phase III, and NIH does not generally provide any Phase III funding to small businesses.
Resources | 56

CROP INSURANCE
The U.S. government has played a role in providing crop insurance to producers of particular sorts of crops across the country since 1938, soon after Franklin Delano Roosevelt announced the creation of an institution to provide insurance for low wheat yields in many states. The program quickly expanded to include what we know as the traditional federal farm support programs, such as corn, wheat and soybeans. Coverage after 1981 expanded greatly as a tool of federal farm policy, and since 1994 includes expanded options for specialty crops.
Protection from price risk and production risk is especially important for fruits and vegetables since these commodities may involve much more risk than do cereal crops. The decision to offer insurance products to certain crops in certain counties is a decision made by the USDA Risk Management Agency. The agency makes available insurance at a lower cost than what might be offered if the commercial insurance industry designed an insurance product, in large part since the aim of the insurance programs are to support agricultural producers (rather than making a profit). Yet even offering an insurance product may be infeasible for the Risk Management Agency if, for example, there are inadequate data to evaluate the actuarial soundness of the product—as is the case with many specialty crops, which are often grown in small volumes and are geographically disbursed.
Whatever the policy aims and program provision difficulties, insurance is a risk management tool for U.S. specialty crop producers, such as those raising fruits, vegetables, and tree nuts. According to the most recent Risk Management Agency report, approximately 73% of the acres devoted to specialty crop production have been covered by federal crop insurance programs. The USDA provides a list of 300 specialty crops that are currently covered by federal crop insurance plans. A specialty crop is defined in law as “fruits, vegetables, tree nuts, dried fruits, and nursery crops (including floriculture),” thus excluding wheat, feed grains, oilseeds, cotton, rice, peanuts, and tobacco.
Whole-Farm Revenue Protection
The Whole-Farm Revenue Protection program was specifically designed to assist producers with diversified operations and provides a wide variety of coverage levels.
It was previously known as the Adjusted Gross Revenue insurance plan, which used documentation of participants from historical IRS Schedule F or equivalent forms and an annual farm report to (1) establish a base; (2) provide insurance for multiple agricultural commodities in one product; and (3) establish revenue as a common denominator for the production of all agricultural commodities. www.rma.usda.gov/policies/
Noninsured Crop Disaster Assistance Program (NAP)
This program provides insurance coverage on crops that are commercially produced agricultural commodities for which crop insurance is not available, examples include:
Eligible causes of loss include damaging weather (drought, freeze, hail, etc). The USDA Farm Service Agency can possibly provide coverage for crops in which the only option through USDA Risk Management Agency is a written agreement. This program also offers an organic option that allows the use of a separate organic average market price where available, instead of the regular established market price. NAP also has a catastrophic level basic coverage as well as buy-up coverage. Basic coverage is $250 per crop with a loss that exceeds 50 percent of expected production at 55 percent of the average market price for the crop. Buy-up coverage offers several different levels of coverage from 50 to 65% and payment rates at 100%. Buy-up coverage is at a premium in addition to the basic level of coverage. Some fees can be reduces for Traditionally Underserved Producers and Beginning Farmers. www.fsa.usda.gov/nap
VOLUNTEER LABOR
World Wide Opportunities on Organic Farms
World Wide Opportunities on Organic Farms
58 | Resources
(WWOOF) is a worldwide movement linking volunteers with organic farmers and growers to promote cultural and educational experiences based on trust and non-monetary exchange. Volunteers (or WWOOFer as they are called) live alongside hosts helping with daily tasks and experiencing life as a farmer. wwoof.net and wwoofusa.org
Internships and apprenticeships might also be an option, though the workers might not be volunteers.
AGRICULTURAL PRODUCTION
University of Wyoming Extension is the outreach arm of UW, especially focused on agricultural, rural, and youth development. Numerous programs and publications are available at www.uwyo.edu/uwe. In addition, each county houses locally based Extension educators and specialists on agricultural production topics of horticulture, animals, range management, and farm and ranch management, each of which is supported by staff on the UW campus in Laramie who are housed in the academic departments listed earlier in this publication. Specific publications and resources include:
High Tunnel Handbook www.wyoextension.org/publications/Search_Details.php?pubid=1831&pub=B-1234
Rural Guide to Community Supported Agriculture www.wyoextension.org/publications/Search_Details.php?pubid=1838&pub=B-1251
Ag & Hort Team of Extension Educators
https://www.uwyo.edu/uwe/programs/ag-and-natural-resources.html
Insuring Success for Western Agriculture
www.insuringsuccess.org
FURTHER READING
The U.S. Food and Drug Administration’s How to Start a Food Business is a guide for food entrepreneurs. www.fda.gov/Food/ResourcesForYou/Industry/ucm322302.htm
The Produce Safety Alliance provides training and resources on FSMA. producesafetyalliance.cornell.edu
Resources | 58
The National Sustainable Agriculture Coalition has a summary of FSMA rules at sustainableagriculture.net/blog/produce-rule-analysis-part-1/
The National Agricultural Law Center has numerous resources, including An Overview of Organizational and Ownership Options Available to Agricultural Enterprises. nationalaglawcenter.org
The IRS provides information about how federal tax laws apply to farming in the Farmer’s Tax Guide at www.irs.gov/forms-pubs/about-publication-225. For more information on federal farm tax management, see the Small Farm Tax Guide, available at www.ruraltax.org/small-farm-tax-guide.
The U.S. Small Business Administration provides comprehensive information about government programs that help new and existing agricultural businesses start, expand, obtain financing, and comply with laws and regulations. www.sba.gov/content/agriculture
A publication intended to help producers sell into wholesale markets is Wholesale Success: A Farmer’s Guide to Food Safety, Selling, Postharvest Handling, and Packing Produce, fifth edition, edited by Jim Slama and Atina Diffley. Click on the ‘Publications’ link on the top of the main webpage at www.FamilyFarmed.org
Food Safety News is media organization that covers topics ranging from policy and politics to foodborne illness outbreaks to sustainability, science, and research. www.foodsafetynews.com/
Farm Commons is a nonprofit that provides free legal education resources on topics including managing food safety liability risk, farm employment law, contracts and sales agreements, recreational activities on farms, and adding value to farm products.
www.farmcommons.org.
Value-Added Grant Program Application Guide The National Sustainable Agriculture Coalition has an online Farmers’ Guide to Applying for the Value-Added Producer Grant Program.
sustainableagriculture.net/wp-content/uploads/2017/09/2017_8-NSAC-VAPG-Farmers-Guide.pdf
Appendix
WYOMING FOOD FREEDOM ACT (2017)
CHAPTER 49
MARKETING HOMEMADE FOODS
1149101. Short title.
This act is known and may be cited as the “Wyoming Food Freedom Act.”
1149102. Definitions.
(a) As used in this act:
(i) “Delivery” means the transfer of a product resulting from a transaction between a producer and an informed end consumer. The delivery may occur by the producer’s designated agent at a farm, ranch, farmers market, home, office or any location agreed to between the producer and the informed end consumer;
(ii) “Farmers market” means as defined in W.S. 357110(a)(xxviii);
(iii) “Home consumption” means consumed within a private home, or food from a private home that is only consumed by family members,employees or nonpaying guests;
(iv) “Homemade” means food that is prepared or processed in a private home kitchen, that is not licensed, inspected or regulated;
(v) “Informed end consumer” means a person who is the last person to purchase any product, who does not resell the product and who has been informed that the product is not licensed, regulated or inspected;
(vi) “Producer” means any person who grows, harvests, prepares or processes any food or drink products on the person’s owned or leased property;
(vii) “Transaction” means the exchange of buying and selling;
(viii) “Process” means operations a producer performs in
the making or treatment of the producer’s food or drink products;
(ix) “This act” means W.S. 1149101 through 1149103.
60 | Wyoming Food Freedom Act (2017)
Wyoming Food Freedom Act (2017) | 60
1149103. Wyoming Food Freedom Act; purpose; exemptions; assumption of risk.
(a) The purpose of the Wyoming Food Freedom Act is to allow for a producer’s production and sale of homemade food or drink products for an informed end consumer’s home consumption and to encourage the expansion of agricultural sales at farmers markets, ranches, farms and producers’ homes by:
(i) Facilitating the purchase and consumption of fresh and local agricultural products;
(ii) Enhancing the agricultural economy;
(iii) Providing Wyoming citizens with unimpeded access to healthy food from known sources.
(b) Homemade food products produced, sold and consumed in compliance with the Wyoming Food Freedom Act shall be exempt from state licensure, permitting, inspection, packaging and labeling requirements.
(c) Transactions under this act shall:
(i) Be directly between the producer and the informed end consumer;
(ii) Only be for home consumption;
(iii) Occur only in Wyoming;
(iv) Not involve interstate commerce;
(v) Not involve the sale of meat products, with the following exceptions:
(A) The sale of poultry and poultry products provided:
(I) The producer slaughters not more than one thousand (1,000) poultry of his own raising during any one (1) calendar year;
(II) The producer does not engage in buying or selling poultry products other than those produced from poultry of his own raising; and
(III) The poultry product is not adulterated or misbranded.
(B) The sale of live animals;
(C) The sale of portions of live animals before slaugh
ter for future delivery;
(D) The sale of domestic rabbit meat;
(E) The sale of farm raised fish provided:
(I) The fish is raised in accordance with title 23 of the Wyoming statutes; and
(II) The fish is not catfish.
(vi) Only occur at farmers markets, farms, ranches, producer’s homes or offices or any location the producer and the informed end consumer agree to.
(d) Except for raw, unprocessed fruits and vegetables, food shall not be sold or used in any commercial food establishment unless the food has been labeled, licensed, packaged, regulated or inspected as required by law. Nothing in this section shall prohibit the sale of homemade food for home consumption from a retail space located at the ranch, farm or home where the food is produced. A retail space selling homemade food under this section shall inform the end consumer that the homemade food has not been inspected and shall display a sign indicating that the homemade food has not been inspected. If the retail space is in any way associated with a commercial food establishment or offers for sale any inspected product, the retail space selling homemade food shall comply with rules adopted by the department of agriculture which shall require:
(i) That the retail space be physically separated from the commercial food establishment with a separate door and separate cash register or point of sale;
(ii) That each separate space shall include signs or other markings clearly indicating which spaces are offering inspected items for sale and which spaces are uninspected;
(iii) Separation of coolers, freezers and warehouse or other storage areas to prohibit the intermingling of inspected and uninspected products;
(iv) Any other requirements specified by the department of agriculture to ensure the sale of homemade foods is made to an informed end consumer.
(e) The producer shall inform the end consumer that any food product or food sold at a farmers market or through ranch, farm or home based sales pursuant to this act is not certified, labeled, licensed, packaged, regulated or inspected.
62 | Wyoming Food Freedom Act (2017)
Wyoming Food Freedom Act (2017) | 62
(f) Repealed by Laws 2017, ch. 111, § 2.
(g) Nothing in this act shall be construed to impede the Wyoming department of health in any investigation of food borne illness.
(h) Nothing in this act shall be construed to change the requirements for brand inspection or animal health inspections.
(j) Nothing in this act shall preclude an agency from providing assistance, consultation or inspection, at the request of the producer.